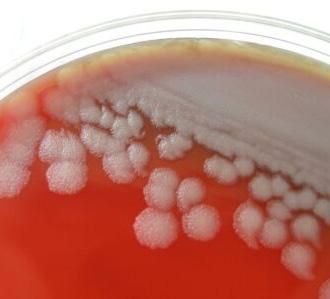

An Integral Investment

What’s in your fall herd health plan?

Peculiar Parasite
Asian longhorned tick populations spread.
Texas Legislative Session Recap
Highlights reported from Austin.










What’s in your fall herd health plan?

Asian longhorned tick populations spread.
Highlights reported from Austin.








Let’s talk about herd health.

From well-managed nutrition to selecting the right genetics, ranchers like you make decisions every day that help keep livestock in tip-topshape. After all, healthy animals are also more efficient — and efficiency equates to profitability.
In this issue, we explore several cattle health-related topics, including delving into herd health plans with two veterinarians in the feature story, “The Most Integral Investment.” Experts share how a solid vaccination protocol, nutrition strategy and management practices safeguard against potential health threats in this coming season and beyond.
Starting on page 20, we learn about a potentially troublesome parasite, the Asian longhorned tick. Because the exotic species is expected to eventually land in the Southwest, we explore risks to cattle raisers, how to monitor and prevent outbreaks, and what to do if an Asian longhorned tick is suspected or identified.
Beyond the traditional realm of animal health, this issue of The Cattleman also recounts how ranchers, landowners and wildlife managers fared during the Texas Legislature’s 88th Regular Session. In many ways, the health of cattle-related politics reflects our freedom to operate. Analyze the most recent policy wins for Texas & Southwestern Cattle Raisers Association on page 26. As always, we hope you enjoy this latest issue and learn something new from its pages. Thank you to our many contributors and supporters! T C
Jaclyn Roberts Parrish Executive Director of Communications & Marketing/ Editor-in-Chief, The CattlemanCORRECTION: In our June feature story titled “Truly Texan,” we regretfully published incorrect data on beef sales and volume through U.S. foodservice. The correct figures are as follows: In 2022, the U.S. foodservice industry was responsible for 8.8 billion pounds of beef sales, returning the sector to pre-COVID levels. This year, projections suggest the foodservice industry will reach nearly 9 billion pounds of beef sales, valued at nearly $46 billion.

“Several years ago I made the switch to Nelson Tetraploid Ryegrass from Gulf ryegrass. NO WAY I’m going back to Gulf... Nelson increases forage production and extends grazing days.
With Nelson, the ranch is producing more Beef, and that means more dollars to our bottom line ... with only a little extra seed cost. The extra production from this switch to Nelson really helps to reduce our costs. (fertilizer and fuel costs)
I’m staying with Nelson Ryegrass! NO WAY I’m going back... My cattle like it... and so do I!”

Cattle
Association P.O. Box 101988 Fort Worth, Texas 76185
Phone: 817-332-7064
Fax: 817-394-1864
Subscription Inquiries: (orders, address change, problems) tscra@tscra.org or 800-242-7820
tscra.org
EDITORIAL
Jaclyn Roberts Parrish Executive Director, Communications & Marketing/Editor-in-Chief jaclyn@tscra.org • 817-916-1794
Jena McRell Managing Editor
Kayla Jennings Proofreader
ADVERTISING
Jana Earp Advertising & Partnership Manager jearp@tscra.org • 817-916-1744
PRODUCTION
Heather Heater Graphic Design & Print Production Manager
Bart Ashford Creative Director
Production support by GRANT COMPANY grantcompany.net
IMPORTANT LINKS
The Cattleman/ TSCRA tscra.org

Cattle Raisers Insurance cattleraisersinsurance.com
Law Enforcement tscra.org, click on Theft & Law
Cattle Raisers Convention cattleraisersconvention.com
America’s




The pitter-patter of rain on a tin roof, along with shrieks from cow kids splashing in puddles, is music to the ears of cattle raisers across the Southwest.
After an unrelenting 2022 summer of extreme temperatures and drought followed by a dry winter, spring brought much anticipated relief. In fact, U.S. Drought Monitor trends indicate much of Texas is currently out of drought conditions at time of press.
Areas of the Panhandle have not looked so green in years, and the pattern

continues all the way to the coast. But as the saying goes, “If you don’t like the weather, just wait a minute.”
As ranchers know all-too-well, agriculture hinges on weather, and animal health is no different. While long-range National Weather Service forecasts predict normal rainfall as the region shifts into an El Niño weather pattern, cattle raisers should still be prepared for anything.
Two experienced veterinarians, one based in Central Texas and the other in the West, offered an outlook on fall herd health and how to stand ready against potential challenges in the next season.

the cheapest insurance.”— Dr. Janey Powe, Idalou Photo by Emily McCartney
Dr. Joseph Blount hails from Hamilton, where he is employed by Trans Ova Genetics, and, with his wife, owns Hamilton Veterinary Clinic and Blount Veterinary Services, specializing in cattle embryo transfer services. He covers a lot of miles and has intimate knowledge of what area ranchers are facing — and says while weather patterns change, his approach to animal health does not.
“I have a very simplistic approach to herd health,” Blount says. “In general, it all wraps back around to cow nutrition. If cow nutrition is good, you’ll see less disease amongst your mature cattle and your nursing calves, as well.”


A sound nutrition plan is allencompassing and results in cattle maintaining adequate body condition to nurse calves and rebreed in a timely fashion. Consulting a nutritionist can help producers find the best combination of protein and mineral with available forage.
“It may be tempting to take your foot off the pedal of the feed truck with the splash of green arriving from the recent rainfall,” he says. “I encourage producers to be as diligent as ever in monitoring body condition scores of their cattle, making sure they have what they need in terms of mineral, protein and forage.”
Hitting the blacktop and moving northwest, Dr. Janey Powe, of Idalou, shares a similar sentiment. In addition to raising cattle of their own, she and her husband own Rocking P Veterinary Services and Lubbock’s Small Animal Emergency Clinic.


Serving clients in the South Plains for 17-plus years, Powe is no stranger to drought conditions. She says the most recent drought was the epicenter of many herd health problems.
“For a long time, we didn’t have any hay or roughage sources at all, and we were shipping them in from different locations,” she recalls. “In this area, we were seeing a lot of magnesium and selenium deficiencies.”
With improved conditions, Powe sees less of these deficiencies. Even so, she says not all hay and pasture sources are the same. Producers should keep that top of mind when addressing cattle nutrition, because it will affect overall animal health.
In fact, Blount says the core of most drought-related disease risks he saw last summer were nutritional.
 Optimal herd health requires a sound vaccination protocol, a watchful eye and high-quality nutrition. Top and middle photos by Kayla Jennings. Bottom photo by Jerod Foster.
Dr. Joseph Blount
Optimal herd health requires a sound vaccination protocol, a watchful eye and high-quality nutrition. Top and middle photos by Kayla Jennings. Bottom photo by Jerod Foster.
Dr. Joseph Blount







Even with recent rain, Blount says pastures are still damaged from prolonged drought and encourages clients to be diligent about monitoring body condition, as it will take time for forage and typical stocking rates to fully recover.
“Droughts are hard on morale,” Blount says. “We start pinching pennies and trying to make the cattle business pencil in these tough times. I can only encourage producers to do what they can to keep their cattle on a positive plane of nutrition.”

Because every operation is different, and no two years are the same, heading into fall 2023 could require additional management considerations. Powe encourages cattle producers to work with their local veterinarian to create a comprehensive herd health plan tailored to their specific needs and goals.
“Herd health programs are the easiest and cheapest way to keep your cattle healthy and prevent disease,” she says. “It’s a really good way to increase your return on investment and feed-to-gain ratio.”
While recent moisture has resulted in replenished forages and comfortable temperatures, it also comes with added disease pressure. Blount says clostridial disease and leptospirosis often come to mind when transitioning from dry to wet seasons.
Clostridial disease spores can be found in uncovered soil from erosion after excess rainfall.
Likewise, leptospirosis is a pathogen that thrives in wet weather as it finds refuge in damp spots and standing water. Blount adds it can be transmitted to cattle through feral swine, which inhabit many areas in the Southwest.
Clostridial disease often develops so rapidly in cattle that death occurs before symptoms can be detected. In addition to reproductive losses, leptospirosis can result in death as soon as three to five days in young calves with anemia, red urine and jaundice.
Fortunately, Blount says there are commercially available vaccines to protect against these diseases.
— Dr. Joseph Blount, Hamilton

Powe says lately she has seen a regional uptick in clostridial disease and leptospirosis, as well as pneumonia. She recommends ranchers be vigilant when checking their herds for signs of illness, so action can be taken before it is too late.
“Looking for signs such as [cattle] going off feed, a snotty nose and coughing need to be watched for sure,” she says.
Powe says cattle going from a dry environment to receiving an abundance of rainfall can also experience bloat, foot rot and fly-borne illness.
In the South Plains, foot rot and abscesses have been common because of the long-term drought, and she doesn’t expect that to slow as fall approaches.
Like Powe, Blount says added moisture and humidity have led to sky-high fly populations.
Since flies lay eggs and emerge from manure, he encourages producers to scrape manure and old hay from pens to dispose of it appropriately, as it can become a fly factory overnight.
“Flies are a giant stress on cattle,” he says. “Fly tags, pour-ons, rubs and IGR [insect growth regulators] are all helpful in slowing them down.”

While flies can transmit just about every disease, Blount and Powe advise to keep a particularly close watch for pinkeye — especially in nursing and weaned calves.
“It can be subtle until the real damage is done,” he explains. “Any squinting, tearing and discharge should be a red flag. Pinkeye can run through a set of calves at an incredible rate and set them back tremendously.”
To finish the year strong and enter the cooler months in ideal condition, cattle raisers can implement simple proactive measures into management plans.

“Herd health, especially in the beef cattle industry, is the cheapest insurance,” Powe says. “You have to always think about return on investment. If you can keep your cattle healthy, parasite free and prevent illness, you’re going to get a better return on your daily gain and your cattle.”
To that point, Blount reports seeing a higher prevalence of worms regionally during the drought over the past year. Because of damaged forages, he expects that to continue, so following a strategic deworming protocol is a solid place to start.
In tandem, he advises producers to vaccinate springcalving bred cows in the fall to boost maternal immunity in calves for clostridial and respiratory diseases.
For fall-calving cows, he says to run them through the chute for pre-breeding vaccinations, including a trusted viral respiratory vaccine covering common reproductive pathogens like vibrio and leptospirosis.
In his experience with cattle reproduction, Blount says these steps have potential to boost breeding rates — and profitability.
“When it comes to the synergy of herd health and reproduction, the take home topic is nutrition, nutrition, nutrition,” he advises. “A well-managed group of cows in good shape will breed up well and be less problematic on the disease side.”
Powe reminds ranchers to also keep weaned calves in mind. Many producers are weaning calves in the late summer and early fall, making it a critical time for preventative health measures.
“You want to be sure to precondition calves with a blackleg vaccine to cover all the clostridial diseases, an upper respiratory combination vaccine including infectious bovine rhinotracheitis, bovine viral diarrhea, bovine parainfluenza -3, and bovine respiratory syncytial virus to optimize calf health prior to weaning,” she says.


“It’s important to talk to your veterinarian to set up a pre-weaning and post-weaning vaccine protocol, and what to look for as far as health condition goes in weaning calves.”
While maintaining a sound vaccination protocol can yield more days by a chute than some cowboys may like, Blount stresses it is better than the alternative. Each time a calf is lost, he says it is like burning a $1,500 check.
“A day vaccinating cows is a lot more fun than a day performing necropsies,” he says. “Cattle prices are expected to be really rewarding for cow-calf guys this next year or two. With the extra value, I hope producers see the importance in making sure every animal on the place is covered.” T C



 Photo by Jerod Foster
Photo by Jerod Foster
Simply hearing the word tick often makes skin crawl. The tiny, blood-feeding parasites are difficult to see, slow to move and pose significant health risks to humans, livestock and a multitude of other hosts.
















Recently, the cattle industry has had sights on a newly emerging, exotic species — the Asian longhorned tick, Haemaphysalis longicornis.









First identified in the U.S. about six years ago on a sheep in New Jersey, the tick is native to Japan, China, parts of Russia and Korea. The multihost tick, roughly the size of a sesame seed, has been found on cattle, horses, dogs, goats, deer and other wildlife, including birds and rodents.
The Asian longhorned tick is concerning to cattle producers because it reproduces quickly and has the potential to spread a disease pathogen resembling bovine anaplasmosis.


Striking up a population of ticks in a new area or within a herd requires only the presence of one female. They reproduce asexually without a male, an oddity among ticks currently found in the U.S., and lay thousands of eggs at a time.







To date, the Asian longhorned tick has been confirmed in 19 states, but not yet in Texas, Oklahoma or the Southwest. Experts agree, it is likely on its way.

From her Stephenville office, Texas A&M AgriLife Extension Specialist Sonja Swiger loads a USDA dashboard for tracking the Asian longhorned tick. Swiger, who is also a professor with a doctorate in entomology, studies how to manage nuisance biting flies and disease-vectoring insects impacting livestock, wildlife and humans.
Two counties in Arkansas with confirmed cases of the Asian longhorned tick are the closest in proximity to Texas. Although, more concerning are three known cases in Missouri, a frequent region for livestock exchange.
“The Asian longhorned tick is continuing to move, but it has been very slow,” Swiger says of the reddish-brown parasite most closely resembling the native brown dog tick, Rhipicephalus sanguineus.
Since it is not host-specific, the Asian longhorned tick has been found on a number of different species in the U.S. and its countries of origin. It is also a three-host tick, meaning it moves from host to host throughout its main life stages, which can take anywhere from roughly 6 months to a year.
“When it is growing, it will find a different host for each of those stages — larvae, nymph and adult,” Swiger says. “Because it can reproduce quite quickly and at high densities, you can get multiple stages on a single host, and that becomes problematic.”
Most ticks are only on an animal for a couple days or weeks, she explains, for however long it takes them to feed. Oftentimes, they are found in the environment. Along the edges of pastures and in areas overgrown with brush.
“With the Asian longhorned tick, it could go anywhere in the state,” Swiger says. “It’s expected it will be brought in by animal movement — whether that’s cattle or a domesticated dog or cat, there is no way to tell. It is really a lot of uncertainty, which makes it tough.”
In addition to general animal health and production threats associated with ticks and tick-borne diseases, the Asian longhorned tick has captured the attention of cattle producers and veterinarians because of a potential pathogen, the Ikeda strain of Theileria orientalis, it is known to carry.
Not generally found in the U.S., this particular strain of Theileria attacks red blood cells in cattle and symptoms mimic those of bovine anaplasmosis.
That’s how Rosalie Ierardi, an anatomic pathologist at the University of Missouri College of Veterinary Medicine, happened on the state’s third confirmed identification of the invasive longhorned tick in August 2022.

She was conducting field research in north central Missouri, searching for the American dog ticks, Dermacentor variabilis, known to transmit bovine anaplasmosis. In their search, they uncovered two nymphs of the Asian longhorned tick.
Rosalie Ierardi’s doctoral advisor, Ram Raghavan at the University of Missouri, has been tracking the spread of various tick species for 15 years.
He led research predicting the Asian longhorned tick’s future migration.
“This map does not mean the tick is in all these places,” Ierardi says. “The darker the color, the more confident the prediction that if the ticks were to get access to those areas, they could potentially survive and thrive there.”
Source: Raghavan et al., 2019
“The finding attracted attention because it was the farthest north in the state that this tick had been identified at that time,” says Ierardi, mentioning the other two findings were confirmed around Kansas City and Springfield, Missouri.


While the Asian longhorned tick does not transmit bovine anaplasmosis, like the winter tick, or Dermacentor albipictus, does in Texas and the Southwest, symptoms of cattle infected with the Ikeda strain of Theileria orientalis can be similar.
Cattle can quickly become anemic, may have a high fever, pale mucous membranes, and elevated heart and respiratory rates. Other symptoms include jaundice, weakness, spontaneous abortions and even death.
Pregnant heifers, calves and other animals with weakened immune systems are particularly susceptible to this and other tick-borne diseases.
“One thing we’ve tried to consistently message to producers here in Missouri is that, if you have what appears to be an increase in cases of anaplasmosis or you are seeing cases in younger calves than you typically do, consider getting in touch with your local veterinarian and testing for this Theileria,” Ierardi says. “There’s really no way to tell them apart without doing a blood test.”


She reminds cattle raisers the presence of the Asian longhorned tick alone does not mean animals will
become sick. It’s the organism the tick carries that causes the destruction of red blood cells and related symptoms.

“Once you have the tick established, then you have to be careful, because if you had some cattle come in that were infected, then the tick could spread it to other cattle,’” Ierardi says. “But just having the tick doesn’t automatically mean you have the Theileria.”
Beyond the herd, human health risks associated with ticks are also a concern.

Swiger says laboratory studies have shown the Asian longhorned tick does not transmit Lyme disease, but it is possible for it to relay Rocky Mountain spotted fever. Although, no cases of the latter have been confirmed.

“If we are going to give the Asian longhorned tick any gold stars, we will give it that one,” she says. “Because we don’t need another tick carrying Lyme disease.”
Texas A&M AgriLife Extension reports an Asian longhorned tick outbreak would add to the $162 million in economic hardship ticks already have on the industry.
Six species regularly affect cattle in the region: Lone Star tick; black-legged tick; winter tick; Gulf Coast tick; brown dog tick; and the American dog tick.
“While we are seeing tick expansion with even our native species moving further north and west, it does take time,” Swiger says. “So that is not something that happens within a few months. It takes years for those changes to occur.”
Ticks alone can pose problems, damaging the hide or causing wounds on an animal. But with any species, larger tick loads can be a serious threat to livestock productivity. If animals are not eating enough or rapidly losing blood, growth is limited and could lead to anemia.
“Most larger cattle can handle tick loads,” Swiger says. “But when you have younger or weaker cattle with lots of ticks, they become anemic really fast and it could be detrimental to them.
“It is important to keep those numbers down, so that you are not impacting your own profits and even maybe your neighbor’s profits by having ticks in an area that’s close enough that they can get to other animals.”
Both Swiger and Ierardi stress the importance of checking newly purchased cattle before introducing into the herd.
“We recommend doing tick checks whenever you bring cattle in to work them,” Swiger says. “Look around their ears, heads, underneath and between their legs. And a lot of ticks will go by the tail.”
The Asian longhorned tick is susceptible to the same repellents and anti-tick treatments used within the
industry. Insecticide ear tags are a proven preventative method for ticks attaching on the upper half of animal; along with using Prolate/Lintox applied as a whole animal spray.
Keeping pastures mowed when possible and avoiding overgrown grasses helps remove tick habitats, as well.
“Ticks can feed on a variety of wildlife species,” Ierardi says. “Even if someone was being really careful and then somehow they ended up finding this tick on their farm — they didn’t do anything wrong. It could literally have come in on a bird or some other type of wildlife species.”
Cattle raisers are encouraged to report any questionable ticks they may find on their animals or property. Ticks can be placed in rubbing alcohol and submitted to a local veterinarian or Texas A&M AgriLife Extension office for testing.
“We have a lot of people who work in the tick field,” says Swiger, referencing AgriLife Extension, Texas Animal Health Commission and USDA. “We are always willing to take samples, so we can be prepared for what we need to do when it’s our turn.” T C
In key locations across Texas, Oklahoma and New Mexico, Helena has branches staffed with people who can provide landowners, ranchers and wildlife enthusiasts with all their management needs.
For more information, contact your local Helena representative or visit HelenaAgri.com.
Pictured on top of a dime for perspective, an adult female Asian longhorned tick is positioned to the right of the younger nymph.





 By Jaclyn Roberts Parrish
By Jaclyn Roberts Parrish
This spring, South Texas rancher and Texas & Southwestern Cattle Raisers Association member Martha Santos was called forward by the Senate Committee on State Affairs in the Texas State Capitol to tell her story. Her testimony revealed ranchers are not adequately protected from liability in certain instances outside of their control.
Santos painted a picture for members of the legislature of her family’s land in Laredo. “Fence line was constantly being cut due to foot traffic, and it became impossible for us or anyone to keep up with,” Santos said.
A downed fence could mean cattle wandered onto public roads, and stolen vehicles could be involved in dangerous crashes — a reality all-too familiar for Santos.
“If a cow gets out in the road and a person hits that cow with their vehicle, the rancher is liable,” she said.
Despite generational roots in South Texas, the liability and risk was so extreme the Santos family was forced to remove cattle from their property.
“Ranchers are tough,” Santos said. “We can shoulder the challenges of drought, bad calf crops, weather and increased input costs, but adding liability for these damages that are not our fault is one burden too many.”
The Santos family’s story brought awareness to a blatant void in the Texas legal system. Liability could still be traced to ranchers who, despite their best efforts, could not prevent these events. It was a reality shared by ranchers in every corner of the state — from fire risks in the Panhandle to flooding and hurricanes along the coast.
Santos’ testimony would go on to support House Bill 73.
Rep. Andrew Murr, the bill’s author, saw it as a bold solution to an emerging and chronic threat faced by the livestock industry. For Murr, H.B. 73 was a personal reminder of impacts felt by landowners.
“Our state’s agriculture industry is one of the most critical elements of our economy, and it is the epitome of our heritage and identity as Texans,” Murr said.
Murr shepherded the legislation alongside Senate-sponsor Sen. Drew Springer.
The bill received widespread bipartisan support, was signed into law by Gov. Greg Abbott, and goes into effect Sept. 1.
H.B. 73, which was based on recommendations from Texas & Southwestern Cattle Raisers Association’s border security task force and survey examining border-related issues, is a tremendous success story. Vital protections will soon be in place for cattle raisers and landowners facing these situations outside of their control.

Meanwhile, other priority legislation born of a similar accord was brewing across the Texas Capitol.
Additional border-related challenges were mounting for ranchers who increasingly faced trespassing, littering and vandalism on their property.
Ranchers like Texas & Southwestern Cattle Raisers Association Director J.R. Ramirez, who operates near La Pryor, went to Austin to speak out.
“In the last eight months, our ranch has had 25 cases of fences or gates being breached by a vehicle,” Ramirez said during testimony to the Senate Committee on Border Security. “The least damaging of those cases is $1,000 minimum.”
These instances add up to significant financial burdens for ranchers and landowners facing razor-thin margins.
“Contributing to the cost is the extent of which cattle escape or mix [with neighboring livestock], which requires many man hours and usually helicopters to rectify,” Ramirez said. “You also have added herd health and disease risks.”
Ramirez spoke in support of Senate Bill 1133, which created a program to compensate landowners for property damages like he described. Sen. César Blanco, who championed the legislation, understood the larger contributions at play.
“With this bill and the $36 million secured in the state budget, hardworking farmers and ranchers will now have financial support from the state of Texas to recover from border-related crimes, so they can get back to delivering food, fiber and fuel across the state and country,” Blanco said.
S.B. 1133, signed by Gov. Abbott, goes into effect Sept. 1.
South Texas rancher and Texas & Southwestern Cattle Raisers Association Director Dustin Dean testified before the Senate Committee on Health and Human Services.

His message to lawmakers, which would go on to support the passage of S.B. 664, relayed shared frustrations of cattle raisers throughout the Southwest over misleading marketing claims of fake meat products.

Dean began by touting the reputation of Texas beef as the safest, most wholesome and environmentally conscious beef in the world. He said, the ability for others to latch onto beef’s positive reputation is unfair.
“We follow the law, and some are laws around how I can and cannot label my beef products,” Dean said. “Unfortunately, some in the alternative protein industry are not transparent with consumers, specifically in labeling.”
As Dean sees it, consumers have a right to choose.
“They [alternative proteins] want the luxury of placing words like cultured or cell-based on the back of their products,” Dean said. “All we’re asking for is a level playing field in the marketplace, and how each [of these] products are described to customers.”
The message was not new for Rep. Brad Buckley and his colleague, Sen. Charles Perry. The appeal for fair labeling of analogue and cell-cultured meat products was an issue the two legislators championed in 2021.


After legislation passed out of the Senate, but failed in the House of Representatives during the 87th Texas Legislative Session, Buckley and Perry spent the interim with partners like Texas & Southwestern Cattle Raisers Association to find a path forward for the bill.
“Texans deserve to know what they are buying at their grocery store,” Buckley said. “By leveling the playing field between traditional and alternative protein producers, we will increase transparency and avoid misleading consumers through misrepresenting alternative protein products.”
Signed into law by Gov. Abbott in May, S.B. 664 requires any analogue or cell-cultured products of meat, poultry, eggs or fish sold in Texas to display a label with the following qualifying terms: analogue; meatless; plant-based; made from plants; cell-cultured; lab-grown; or similar language.
Private property rights are paramount to ranchers and landowners. However, changing demographics across Texas and the U.S. have resulted in new threats to agriculture. Individuals and groups have taken advantage of loopholes and outdated language in traditional legal protections — including the state’s Right to Farm Law.
“The population is growing,” said Stephen Diebel, Texas & Southwestern Cattle Raisers Association second vice president and secretary/treasurer during testimony before the Senate Committee on Water, Agriculture and Rural Affairs. “That growth impacts rural parts of the state as new neighbors and businesses move into traditionally rural areas.”
According to the U.S. Census Bureau, the state’s population surpassed the 30-million mark in 2022, sparked by a 9 million resident increase from 2000-2022. The Lone Star state also loses rural land faster than any other state in the nation.
With this growth comes conflict.
Diebel said a Texas & Southwestern Cattle Raisers Association member’s stocker operation could have been in jeopardy when a wedding and event venue moved across the road from the operation three years ago.
Top — Sen. Charles Perry worked across the aisle, chambers and industries for priority bills like H.B. 2308, H.B. 1750, S.B. 664 and S.B. 1133.“Eventually the wedding venue began complaining that the sound and smell of the cattle were a problem because they interfered with the ambiance of the venue,” Diebel said. “These complaints have not yet led to a legal challenge, but they persist today and illustrate the new challenges agriculture faces.”
H.B. 2308, also known as Rural Right to Farm, championed by Rep. Trent Ashby and Sen. Charles Perry, sought to change that. The legislation was structured to protect rural agricultural operations from nuisance complaints and other legal challenges.
It also went a step further and extended protections to farmers and ranchers who choose to expand their original operation, so long as the operation had been in existence for one year.
Ashby is proud of the legislation he helped champion protecting rural Texas.
“House Bill 2308 not only strengthens protections for agriculture operations, but also reaffirms our commitment to the farmers and ranchers who play a critical role in delivering the food and fiber to our growing population,” Ashby said.
H.B. 2308 was not the only legislation bolstering Right to Farm provisions.
Another noteworthy initiative, H.B. 1750, which was championed by Perry and Rep. DeWayne Burns, compliments the rural-focused legislation to provide additional rights for operations within, or near, city limits.
H.B. 1750 requires cities to provide evidence of a public health threat when regulating agricultural operations. This means that operations cannot be condemned without scientific proof of harm to residents, which is stipulated in legislation to come from verified sources including Texas A&M AgriLife Extension.
Together, H.B. 1750 and H.B. 2308 provide comprehensive protections to the Texas Right to Farm Law. The bills were signed by Gov. Abbott and go into effect Sept. 1.
Not all efforts in Austin are about passing bills. On occasion, it is about stopping them.



With the emergence of carbon storage markets in the last years, much buzz has surrounded the marketplace’s regulatory framework.
Several bills were introduced in an attempt to better define and regulate carbon storage markets, as well as offer carbon storage companies financial incentives and special, broad-reaching exemptions from liability laws.
One piece of legislation significantly threatened the private property rights of landowners. The proposed bill introduced a process called integration, in which carbon storage companies could force landowners to store carbon under their land without their consent.
Natural Resources and Economic Development Committee Chairman, Sen. Brian Birdwell, led discussions considering proposed carbon legislation's impact on all Texans — and the importance of landowner private property rights.For Texas & Southwestern Cattle Raisers Association Director Dan Gattis, the concept was alarming.
“Integration is not condemnation — it’s worse,” Gattis said during testimony to the Senate Committee on Natural Resources and Economic Development. “If I go through condemnation, I get a right to a judge and jury in my community who determine what true fair value is.”
Integration does not provide a landowner with those same rights, and it closely resembles another concept in the oil and gas industry — forced pooling, which Texas & Southwestern Cattle Raisers Association has long been opposed to.
Like integration, forced pooling would give oil and gas companies the right to force individuals to relinquish their private property and submit to contract terms drafted by others, when a majority percentage of mineral owners agreed to enter into leases with oil and gas companies.
Forced pooling has consistently been rejected by the Texas Legislature as an unfair violation of private property rights.
Thanks to the hard work of Texas & Southwestern Cattle Raisers Association and its members and many other partners, integration was also rejected.

The concerns about the erosion of private property rights led to similar concerns over legislation to remove liability from corporations storing or transporting carbon on private property.
In doing so, companies would be voided of an obligation to store carbon in a safe way and to preserve the land from harm.
“If I don’t know what’s being injected underneath me, that’s a problem,” Gattis said.
As Gattis saw it, the legislation was premature. Texans are already entering into carbon storage contracts with oil and gas companies, and successfully without companies being granted protection from liability.

Legislature leadership from Lt. Gov. Dan Patrick and members of both chambers, including the bill authors themselves, listened to concerns raised by Texas & Southwestern Cattle Raisers Association members.
The result was significantly altered or defeated legislation — preserving the treasured principles of private property rights and accountability. T C

In many ways, the 88th Regular Session of the Texas Legislature broke records. With a surplus of more than $32 billion to the state budget and 8,000-plus bills filed by legislators, Texas & Southwestern Cattle Raisers Association faced a tough road in Austin.

The busy legislative session brought welcomed news to ranchers and landowners who are better off after a tremendous 140 days. All Texas & Southwestern Cattle Raisers Association recommendations, as well as other beneficial legislation, were passed. Equally important, detrimental legislation did not.
Texas & Southwestern Cattle Raisers Association leaders and staff dedicated hundreds of hours to ensure the voices of ranchers and landowners were heard.
Across the state, Texas & Southwestern Cattle Raisers Association members stepped up — calling legislators, reviewing legislation and driving to Austin to give testimony across seven different legislative committees.
No legislative session can be a success without policymakers, leadership and legislative staff who listen to Texas & Southwestern Cattle Raisers Association’s concerns and perspectives and take a stand for ranchers and landowners.
I, along with many others, offer a heartfelt thanks to them.
Texas & Southwestern Cattle Raisers Association is one of the few professional association voices in Austin advocating for ranching, private property rights and the beef industry. The reputation of the association, established by you, our members, also makes us one of the most prominent and hardworking associations in both the state and nation’s Capitols.
It is a true honor and privilege to work on your behalf.
However, we cannot continue to be this political force without our members. It takes your engagement and financial commitment.
Please keep your membership current and encourage others to join. Please also consider donating to the Cattle Raisers PAC. Members can donate by sending a check to the Fort Worth or Austin office or online at tscra.org.
Most importantly, stay connected with us and let us know what issues are most important to you. In coming together, we will continue to represent a strong, united force in Austin and Washington, D.C. T C

Texas & Southwestern Cattle Raisers Association recognizes the following policymakers and leaders for dedicated efforts to the state’s ranchers, landowners and rural citizens during the 88th Legislative Session.

































Join

JOIN YOUR FELLOW CATTLE RAISERS
SEPT. 25 | COLLEGE STATION
The 2023 Young Cattle Raisers Skeet Shoot & Dinner brings together the next generation of ranchers, landowners, wildlife managers and others who are interested in the future of the great Southwest. Young producers aged 25-40 can connect with like-minded individuals to network, learn more about Texas & Southwestern Cattle Raisers Association and enjoy an afternoon of skeet shooting.

SEPT. 25 - 27 | COLLEGE STATION
Attend the 2023 Texas & Southwestern Cattle Raisers Assocation Policy Conference to learn the latest updates across emerging issues and develop policies to drive the association’s efforts for years to come.

Member or not, join TSCRA at one of many local events to connect and learn about the latest in the cattle industry over a great beef meal with fellow ranchers, landowners and those who live for this land.

August 3 – Crockett
August 21 – Beaumont
August 29 – Decatur
September 6 – Stephenville
September 13 – Waco
September 28 – Amarillo
October 3 – Houston
October 10 – Throckmorton
October 16 – San Angelo
October 25 – Mt. Pleasant
October 27 – Victoria
November 9 – Fredericksburg
November 16 – Brenham
November 28 – San Antonio
December 6 – Edinburg
To register or learn more about these opportunities, visit TSCRA.org.
Association members met June 8-9 in Marfa.
Texas & Southwestern Cattle Raisers Association hosted its two-day Summer Meeting this year in Marfa, where more than 200 members learned about key issues impacting the cattle industry and conducted important association business.

Attendees heard from Melissa Hamilton, Texas & Southwestern Cattle Raisers Association executive director of government relations, for an 88th Texas Legislature recap.
Other speakers included: Dr. Andy Schwartz, Texas state veterinarian, who shared updates to ongoing traceability efforts to combat disease outbreaks in cattle and deer; Parks Brown, partner at Uhl, Fitzsimons, Burton, Wolff and Rangel PLLC, who provided an overview of carbon sequestration and alternative energy markets; Dr. Sara Wycoff, wildlife veterinarian at Texas Parks & Wildlife Department, who shared the latest on Chronic Wasting Disease in Texas deer populations; and Brett Stuart, founder and president of Global AgriTrends, who discussed the effect of global imports and exports on the overall U.S. beef supply.
In addition to a robust speaker lineup, the Texas & Southwestern Cattle Raisers Association board of directors convened for the second time this year.
The association will meet again Sept. 25-27 at its Policy Conference in College Station.
Texas & Southwestern Cattle Raisers Association will host five football tailgates this fall.
Sept. 9 — Texas Tech University
Sept. 30 — West Texas A&M University
Sept. 30 — Texas Christian University
Oct. 21 — Tarleton State University
Oct. 28 — Texas A&M University
The events are targeted to attract both college alumni as an appreciation of membership and also college students to join the association. For more information, visit tscra.org/events.
Texas & Southwestern Cattle Raisers Association invites all young producers and young professionals aged 25-40 to a networking event and dinner with the association’s board of directors.
The effort is led by the organization’s leadership development committee, which focuses on future association leadership by creating educational and fostering networking opportunities for youth and young producers.
The gathering will be held the afternoon of Monday, Sept. 25, prior to the start of TSCRA Policy Conference, in College Station at Tonkaway Ranch.
A nominal registration covers fees for skeet shooting as well as a delicious beef dinner. Young professionals can register by emailing education@tscra.org.
For more information on this and other association activities, visit tscra.org/events. T C



Mark and Cheryl Brown have been awarded the state’s highest honor for private land conservation, the Leopold Conservation Award, which was presented at the Lone Star Land Steward awards banquet May 25 in Austin.
The Brown Ranch, located in Ammansville in Fayette County, was previously awarded the Lone Star Land Steward Blackland Prairie ecoregion award in 2017.
Since then, the couple has continued superlative conservation work on tall-grass prairie restoration and community outreach.
The prestigious award, given in honor of renowned conservationist Aldo Leopold, recognizes extraordinary achievement in voluntary conservation and natural resource management by American ranchers, farmers and foresters in 22 states.
In Texas, the award is presented by the Sand County Foundation and national sponsor American Farmland Trust, in partnership with the Texas Parks and Wildlife Department as part of the Lone Star Land Steward Awards program, which is supported by the nonprofit Texas Parks and Wildlife Foundation.
Plant surveys have uncovered more than 250 species of native plants on the parcels owned by the Browns. Annual bird surveys on the property have located focal species for conservation efforts — including loggerhead shrike, dickcissel, grasshopper sparrow, eastern meadowlark and many more — due to their significant population declines over the last half-century.
Craig Haythorn, one of the most respected ranchers and horsemen in the nation, will receive the National Golden Spur Award at the Buddy Holly Hall of Performing Arts & Sciences in Lubbock, during the annual National Golden Spur Award Honors Friday, Nov. 3.

Haythorn, of Haythorn Land and Cattle Co., in the Sandhills of Arthur, Nebraska, will be the 45th recipient of the National Golden Spur Award for accomplishments by a single individual in the ranching and livestock industries.

Presentation of the National Golden Spur Award is a joint annual recognition historically given by six of the leading state and national ranching and livestock organizations: the American Quarter Horse Association; National Cattlemen’s Foundation; Ranching Heritage Association; Texas Cattle Feeders Association; Texas Farm Bureau; and Texas & Southwestern Cattle Raisers Association.
Haythorn is the fourth generation in his family to own and operate Haythorn Land and Cattle Co. after his greatgrandfather immigrated from England as a 16-year-old stowaway on a ship headed to America.
Moving four generations into the future, Craig was four years old when he went on his first cattle drive and 13 when he was put in charge of the hay crew. Today, the 76-year-old rancher leads the fourth, fifth and sixth generations of the storied Haythorn Land and Cattle Co.
Craig’s grandfather had the first registered American Quarter Horse Association stud in Nebraska, and the Haythorns were awarded the first-ever AQHA Remuda Award in 1992. Their company is one of the largest and most respected breeders of American Quarter Horses in America.
Tickets for the National Golden Spur Award Honors are now on sale at goldenspurhonors.com.
you can reward your own family with the trip of a lifetime. Going on now, commit to a Fendt tractor, Momentum planter, Ideal combine, or Fendt Rogator before August 31st, 2023 and receive a FREE trip to Germany in November 2023! Travel with Parallel Ag through Berlin, Munich, to Hanover for Agritechnica (the world’s largest farm show), visit the Fendt factory in Marktoberdorf, and so much more. Discover the history of this more than 90-year-old company that has proven itself to be elite in countless ways.


When you improve your operation with machinery from the Fendt family
The Houston Livestock Show & Rodeo, a longstanding institution in the heart of Texas, May 25 announced Pat Mann Phillips was elected as its new chairman of the board.
The historic announcement marks a new chapter for the rodeo, as Phillips is the first woman chairman since the show began in 1932. Phillips succeeds Brady Carruth, who served as chairman since 2020.
Phillips first joined the rodeo as a volunteer in 2001, working with several of the organization’s committees. In 2009, she was founding chair of the tours committee and was integral in laying the groundwork for the committee’s continued success today.

Phillips was elected to the board of directors in 2012 and served as a rodeo vice president from 2016 to 2018, overseeing the efforts of the transportation, magazine, special children’s, agriculture education (formerly Ladies’ Go Texan), souvenir program, and communications and special services committees.
In 2018, she was elected to serve on the executive committee, and named chairman of the board elect in 2022.
In addition to electing Phillips as the new chairman of the board, the rodeo’s executive committee also appointed Jeffrey S. Hayes and J. Alan Kent to the 2024 board of directors. Both individuals have been stand-out volunteers and life members of the rodeo, committed to leading the organizations 35,000-plus volunteers.
Texas Gov. Greg Abbott appointed Annie Valicek, a senior agribusiness and economics major at West Texas A&M University in Canyon, as the next student regent for the Texas A&M University System.
A Houston-native, Valicek is the university’s immediate past student body president and a former intern with Texas & Southwestern Cattle Raisers Association.
She is also a founding member of West Texas A&M’s Collegiate Farm Bureau chapter and is chair of career and personal development for Chi Omega sorority. Valicek plans to attend law school after graduation.
In 2005, the 79th Texas Legislature authorized the governor to appoint non-voting student regents to each university system’s board of regents. The chancellor of each university system recommends at least two students to the governor from applications submitted by participating universities. The Texas A&M System’s Board of Regents meets quarterly with special meetings arranged as needed. T C
Elements of the equation to be discussed during upcoming Ranching 101.
Texas & Southwestern Cattle Raisers Association invites its members to participate in a virtual Ranching 101 session at 1 p.m. Tuesday, Aug. 15.
During the hour-long Zoom webinar, attendees will gain a better understanding of the various factors impacting cow cost.
An expert speaker will share how to determine the total expenditures associated with raising cattle and how to gain a clearer overall financial picture.
Interested? Scan the QR code to register.

A monthly webinar series hosted by Texas & Southwestern Cattle Raisers Association’s events and education department, Ranching 101 explores fundamental principles of beef cattle production.

Experienced or brand-new cattle raisers will find something of value during these online sessions. Registration is complimentary for any association member. Visit tscra.org to learn more. T C

SpecialReplacementFemaleSales
Saturday,Aug.26@10:00a.m.–SanSaba
ConsignmentsWelcome!
Saturday,Sept.23@10:00a.m.–SanSaba
ConsignmentsWelcome!
*Wednesday,Oct.18@11:00a.m.–SanSaba
10THAnnualHillCountryYouthHeiferSale
SpecialBullSales
Thursday,Oct.12@10:00a.m.–SanSaba
Featuring15BrangusBullsfromMartin-BruniCattle, 20HerefordsfromHiddenOaksRanch &25CharolaisBullsfromSimmonsCharolais.
BooksareClosed!
ReplacementFemaleSale
Saturday,Oct.28@10:00a.m.–SanSaba Offeringqualitypair,bredcows, bredheifersandopenorexposedheifers. Don’tmissyouropportunitytobuysome ofthebestfemalesinthecountry! Thesellerandbuyerofthetop-sellingfemales ineachoftheclasseswillreceiveatrophy. Allcattlewillbefiveyearsofageoryounger! ConsignmentsWelcome!
WEEKLY SALES HELD AT 11:00 a.m.
Monday – Mason
Thursday – San Saba
Formoreinfoonabove salesoronlineviewing andbidding,pleasecall orvisitourwebsite.





Temple Grandin’s Guide to Working With Farm Animals: Safe, Humane Livestock Handling Practices for the Small Farm

Available on Amazon and Storey.com
GRANDIN LIVESTOCK SYSTEMS, INC.
2918 Silver Plume Dr., Unit C3• Fort Collins, CO 80526 970-229-0703 • www.grandin.com

BOVINE
for tick-borne diseases such as Lyme, Theileria, and Babesia are also available. Call for more information.
To schedule or discuss your testing needs, contact MatMaCorp at: Phone : 402-742-0357
Email : bchf@matmacorp.com
www.matmacorp.com
At Cactus Feeders The Cattle Come First, and Our Cattle Feeding Customers are the Core of Our Business


Get to know the individuals who make Cactus Feeders a success.
Cactus Feedyard
Matthew Turney, Manager Cactus, TX office: (806) 966-5151 cell: (806) 282-7077
Centerfire Feedyard
Rusty Jackson, Manager Ulysses, KS office: (620) 356-2010 cell: (806) 773-9457
Frontier Feedyard
Ross Kelso, Manager Spearman, TX office: (806) 882-4251 cell: (806) 662-4741
Stratford Feedyard
Pistol Audrain, Manager Stratford, TX office: (806) 396-5501 cell: (806) 753-7133



At Cactus, our Employee Stock Ownership Plan (ESOP) makes each employee an owner of the company. They think like owners and take care of the cattle like owners. That’s the secret to what has made Cactus Feeders a success, and that will continue to make us successful tomorrow.
Southwest Feedyard
Kacey Graham, Manager Hereford, TX office: (806) 364-0693 cell: (806) 316-8799
Hale Center Feedyard
David Watts, Manager Hale Center, TX office: (806) 879-2104 cell: (806) 202-0209
Ulysses Feedyard
Adam Gerrond, Manager Ulysses, KS office: (620) 356-1750 cell:(806) 390-9034
Wolf Creek Feedyard
Keith Brinson, Manager Perryton, TX office: (806) 435-5697 cell: (806) 282-7588
Wrangler Feedyard
Randy Shields, Manager Tulia, TX office: (806) 583-2131 cell: (806) 290-0559







Syracuse Feedyard
Phil Moreman, Manager Syracuse, KS office: (620) 384-7431 cell: (806) 340-4790
More than $32,000 in stolen feed, hay and equipment returned to the lawful owner.
Texas & Southwestern Cattle Raisers Association
Special Rangers Bo Fox and Robert Pemberton, along with local Anderson County investigators, recovered 225 bales of alfalfa, 10 tons of livestock feed and other livestock-related equipment, totaling more than $32,000 of stolen property.
During an intensive fraud investigation, information led special rangers and Anderson County officials to a residence near Cayuga. While inspecting the residence, hay, feed and equipment were discovered that matched the description of previously reported stolen property to Texas & Southwestern Cattle Raisers Association and the Hubbard Police Department.
Further investigation revealed the Anderson County landowners were victims of fraud. The assets were acquired through fraudulent credit card transactions, then sold to the Anderson County landowners through an online sale.
The Anderson County landowners were not charged, and the property that was found was returned to its lawful owner.
Texas & Southwestern Cattle Raisers Association, in partnership with other local investigators, continues the search to identify those responsible for the stolen property. Anyone with information about this case is urged to come forward.
Special rangers arrest Angel Bazaldua for failing to pay for two loads of goats.
Angel Bazaldua, of Uvalde County, was arrested on felony theft charges for failing to pay for two loads of goats from the Southwest Livestock Exchange. The arrest is the result of an investigation led by Texas & Southwestern Cattle Raisers Association Special Ranger Joe Aguilar Jr.
In May 2022, Bazaldua purchased 272 goats from the Southwest Livestock Exchange. The following week, he purchased an additional 388 goats from the same auction barn.
To take possession of the second load of goats, the auction requested Bazaldua first pay for the initial livestock purchase. Bazaldua wrote a check for $35,000. Within days, the bank alerted the auction owners Bazaldua ordered a stop payment for the check.
An investigation led by Texas & Southwestern Cattle Raisers Association led to Bazaldua’s arrest for thirddegree felony theft totaling $79,420.
Clinton Ray Fleming was arrested by special rangers for embezzling more than $46,000.
Clinton Ray Fleming, of Cushing, Oklahoma, was arrested on felony charges for an embezzlement scheme to steal more than $46,000. The arrest is the result of an investigation led by Texas & Southwestern Cattle Raisers Association Special Rangers Cody Hyde and Brad Oliver.
The arrest is built on a case that Fleming stole $9,550 worth of saddles and tack, and sold five registered Quarter Horses valued at more than $28,500 — all belonging to his former employer. The investigation revealed Fleming accepted an additional $8,620 as payment for three different registered Quarter Horses and their training, but he never delivered them.
Shortly after, Fleming ceased all communication with both victims and fled the area.
Fleming was located by working on a ranch near Farmersville. Hyde and Oliver obtained consent to search the ranch and recovered $3,950 of his former employer’s tack.
Taken into custody on a felony warrant, Fleming was transported to McKinney and booked in the Collin County jail to later be extradited back to Oklahoma.
The eight horses and some tack have yet to be recovered. The missing horses include a 3-year-old sorrel mare, a dun stallion colt, another sorrel mare, a 10-year-old bay mare, two 5-year-old grey dapple mares, a 4-year-old bay roan and a 6-year-old grey mare.
Texas & Southwestern Cattle Raisers Association special rangers continue to investigate and request potential victims who believe they may have been subject to Fleming’s scheme or individuals with information about the case contact the Operation Cow Thief tip line at 817-916-1775 or Hyde at 918-315-2925.
The association would like to thank the Payne County Sheriff Joe Harper and Payne County District Attorney’s office for their joint efforts in this investigation to successfully bring the case to prosecution. T C



UTV stolen near Bowie.
Texas & Southwestern Cattle Raisers Association
Special Ranger John Vance reports a 2019 ranchedition Kawasaki Mule stolen near Bowie. The VIN number is JKBAFSJ10KB510531. The mule is brown with one row of seating, a dump bed and after-market lighting on the front bumper. It also has several stickers on it, including a red Texas & Southwestern Cattle Raisers Association sticker on the front-left fender. Anyone with information on this case is urged to contact Vance at 903-438-6251.
Heifers missing in Fannin County.
Texas & Southwestern Cattle Raisers Association
Special Ranger Brad Oliver reports three heifers missing from a pasture off Fannin County roads 4020 and 4025. The missing heifers include one Brangus, one gray Brahman and one red-brindle-colored heifer with a white face. They all weigh approximately 700 to 800 pounds and are branded on the left hip with =BL=. They also have a yellow or white tag in right ear. Anyone with information on this case is urged to contact Oliver at 903-328-8023.
Equipment stolen near Carthage.
Texas & Southwestern Cattle Raisers Association
Special Ranger Larry Hand reports a John Deere tractor, Legend Force auger and a Predator 3500-watt generator stolen from a property off U.S. Highway 79 South. The tractor is a 2018 model 5115M with a cab, front-end loader and bucket.
The serial number of the tractor ends in 2312, and the serial number of the loader ends in 9785. The suspect(s) entered the property June 2 between 9:30 p.m. and 10 p.m. Anyone with information on this case is urged to contact Hand at 903-571-3488.
19
Trespasser(s) wanted in Crockett County.
Texas & Southwestern Cattle Raisers Association
Special Ranger H.D. Brittain reports trespassing in Crockett County. The unknown suspect(s) entered the property May 12 and possibly darted exotic game
animals. Information leading to an arrest or indictment of involved parties is eligible for a reward. Anyone with information on this case is urged to contact Brittain at 325-340-2268.
Skid steer stolen near Ledbetter.
Texas & Southwestern Cattle Raisers Association
Special Ranger Kenny Murchison reports a Melroe Bobcat skid steer, model 773, stolen in Lee County. The PIN number is 517616369. The skid steer was stolen between 5 p.m. May 10 and 2 p.m. May 11. The suspect(s) stole it from a barn and drove it through two fences. Anyone with information on this case is urged to contact Murchison at 512-705-3226.
Cows missing in Washington County.
Texas & Southwestern Cattle Raisers Association
Special Ranger Brent Mast reports two Charolais cows missing. The cows are branded with a lazy R on the right hip and were last seen early April. Anyone with information on this case is urged to contact Mast at 936-714-6619.
23
Pickup and trailers stolen near Houston.
Texas & Southwestern Cattle Raisers Association
Special Ranger Mike Boone reports two separate thefts on the same property in Harris County. Two pickups and two trailers were reported stolen. One pickup was recovered in Montgomery County. The missing trailers and other pickup are described as follows:
• A white, 2001 Dodge 3500 dually 4-door pick-up with primer-colored fenders and a black Ranch Hand bumper;
• A 16-foot, homemade, blue and white gooseneck livestock trailer; and
• A 20-foot, homemade, red-orange gooseneck livestock trailer.
The owner is offering a $30,000 reward for information leading to the arrest and conviction of suspect(s) involved. Anyone with information on this case is urged to contact Boone at 409-658-5725.
25
Equipment stolen in Gonzales.
Texas & Southwestern Cattle Raisers Association
Special Ranger Robert Fields reports a mini excavator, bumper-pull trailer, welding machine and Metabo air compressor stolen on May 15. The mini excavator is a 2007 Bobcat model 331G, with an 18-inch bucket and missing front blade. The PIN number is 234317133, and it has approximately 1,800 hours on it. The bumper-pull trailer is a 2019, 20-foot lowboy Big Tex model 14TL. The trailer
VIN number is 16VEX2029K2042578, and the license plate number is FVWM48. The welding machine is a Hobart Champion with approximately 200 to 300 hours.
Trailer stolen in Victoria.
The special ranger also reports a 2004, 24-foot Gooseneck aluminum stock trailer stolen. The VIN number of the trailer is 16GA3242X4B078598 and the license plate number is FYGJ87. The trailer was stolen May 18 by two male suspects who broke into the property. They were driving an early 2000 model, white, single-cab Ford pickup with a long bed.
Burglary near Nordheim.
Fields reports an attempted burglary to a barn off Talk Ranch Road. May 4 at around 5:49 a.m., an unknown male subject was captured on a doorbell camera attempting to make entry into the residence. The suspect was wearing a baggy shirt, gloves and hat to mask his identity. After an attempt to open the door of the residence, the suspect pried open the locked door of the barn and made entry. Anyone with information on these cases is urged to contact Fields at 361-207-5207.

Heifers missing near Fredericksburg. Texas & Southwestern Cattle Raisers Association Special

Ranger Todd Jennings reports two heifers missing in northern Gillespie County. One Hereford has an ear tag in the left ear with the letter R. The other heifer is a blackand-white Angus cross and has an ear tag with the letter W in the left ear. The heifers were last seen Feb. 15.
Bull missing near Willow City.
Jennings also reports a black Angus bull missing from a property off Althaus Davis Road in northern Gillespie County. Last seen around May 4, the bull is branded with HIL and 957 on the left hip and has a white ear tag in the left ear. Anyone with information about these cases is urged to contact Jennings at 830-997-7585.
Tractor stolen in Jim Wells County. Texas & Southwestern Cattle Raisers Association Special Ranger Steve Martin reports a 2016 New Holland T4100 tractor stolen. Last seen May 26, the tractor has a front-end loader and the VIN number is ZFLE50685. Anyone with information on this case is urged to contact Martin at 361-542-0496. T C
TSCRA offers a cash reward for information leading to the arrest and/or grand jury indictment of individuals for theft of livestock or related property. Anonymity is guaranteed. To provide information, call the Operation Cow Thief tip line at 817-916-1775.
Be sur e to watch for our September ad w hich will featur e a QR code that will dir ect you to our Video Catalog, so you can see videos of each bull.





It is a simple phrase most have said a time or two. While commonly first nature to assume all individuals as honest and genuine, unfortunately that is not always the case.
Scott Williamson, Texas & Southwestern Cattle Raisers Association’s executive director of law, brand and inspection services, was a recent guest on the TSCRA Talk podcast to provide tips for preventing theft and crime across the agricultural industry.

The industry veteran said in previous years crime was dominated by theft investigations, such as lock cutting and cattle rustling. In recent years, fraud has become more prevalent — especially with the help of digital platforms.
Stories like a recent case in South Texas are all-tofamiliar to the Texas & Southwestern Cattle Raisers Association special ranger team. An individual purchased thousands of dollars of hay, and it was never delivered.
Williamson advised ranchers to be diligent before making deals.
“Get a reference, find somebody in that area who might be able to go over and look at the hay or tell you about that person’s integrity, and even feel free to call the special rangers,” he said. “If it sounds too good to be true, it likely is.”
A clear bill of sale is another critical component that could help buyers avoid fraudulent activities.
“My suggestion is never to make a payment until you have received it,” Williamson said.
This ensures buyers can verify the product is as described. If it fails to meet the advertised standards, Williamson reminded ranchers they have a right to return the product and not unload it.
He also noted the increasing occurrence of fraudulent cashier’s checks. This is often found in livestock buyer and seller agreements. He suggested working with a local bank to run the numbers to confidently tell if the seller is legitimate or not.
In the unfortunate instance that fraud, theft or another crime occurs, Williamson reminded ranchers it is vital to file reports in a timely manner.
“You don’t have to be neck deep in a crime before you call us,” he said.
Williamson was raised with freedoms that are now foreign in most areas. Locking gates and barns daily is a note Williamson suggested to ranchers. Although it is frustrating in day-to-day production, it allows producers to notice if a non-resident has stepped foot on the property.
“You don’t have to notice something is missing before you realize somebody has been on your property,” Williamson said.
Next on the expert’s list of advice: keep a detailed list of serial and vehicle numbers. Recording pictures of the identification numbers creates a higher level of efficiency if property comes up stolen and a special ranger begins an investigation.
Digital media may have spurred a new era of crime, but landowners can also use new technology to their advantage.
In addition to Texas & Southwestern Cattle Raisers Association posted signs, trespasser warnings and purple paint on gates, investing in cameras can offer valuable evidence.
Cameras that immediately send pictures to a mobile device is Williamson’s best suggestion when selecting equipment that best fits an operation. Since cell phones are constantly accessible, they allow faster connection and offer huge security benefits.
And never underestimate the value of watching out for neighbors.
“The fastest way to reduce crime is when everybody is aware and taking care of themselves and their neighbors,” Williamson said. “Don’t think of your neighbors as being nosy and don’t hesitate to be a nosy neighbor.”
To hear more of the conversation on agricultural crime prevention, download TSCRA Talk on any podcast platform. Also visit tscra.org for a map and directory of special rangers throughout Texas and Oklahoma. T C


For more than half a century, TCU’s renowned Ranch Management program has given students an edge in agricultural resource success. This unique nine-month intensive program equips graduates with real-world strategies as producers and land stewards in changing times.

Space is limited. Visit ranch.tcu.edu or call 817-257-7145.

During summer months, livestock producers and outdoor enthusiasts across the state, especially those in South Texas, have more to think about than rising temperatures.
Anthrax, sometimes incorrectly referred to as bovine anthrax, is a bacterial disease caused by Bacillus anthracis, which occurs naturally in soil.
Texas A&M Veterinary Medical Diagnostic Laboratory historically sees a rise in positive cases in June, July and August, followed by a slow decrease through September and October.
How concerned should cattle raisers be about anthrax? Two Texas A&M AgriLife experts weigh in and explain what anthrax is and what to do if a positive case is suspected.

Dr. Terry Hensley is the laboratory’s assistant agency director and a Texas A&M AgriLife Extension Service veterinarian. He has broad knowledge of veterinary medical topics and has been a valuable resource for the Texas Animal Health Commission, Texas Parks and Wildlife Department, and the public during previous outbreaks.
Dr. Narayan Paul is a board-certified veterinary clinical microbiologist and the bacteriology section head for Texas A&M Veterinary Medical Diagnostic Laboratory, where anthrax testing takes place.
Hensley: Anthrax is not contagious like the flu. The most common route of infection is by ingestion of the bacterial spores from contaminated forage, soil or water. Infection by inhalation or through skin wounds is also possible. The disease can infect all animals with some being more susceptible than others. Herbivores such as cattle, sheep, goats and horses, as well as wild herbivores like deer, are more susceptible than swine and carnivores such as dogs.
Hensley: Humans are considered relatively resistant to anthrax; more resistant than cattle, but less resistant than dogs. Cases in humans are uncommon in the U.S. In rare circumstances, infection could be acquired from the inappropriate handling of the carcass of an animal that died of the disease. The source of infection
Top: Herbivores are more susceptible to contracting anthrax than humans or carnivores.
Bottom: Bacillus anthracis , the causative bacteria of anthrax, on sheep blood agar illustrating ground-glass, dry colonies and non-hemolytic colonies.
Photos courtesy of Texas A&M AgriLife.

Bred,

would most likely be by ingestion, inhalation or wound contamination by anthrax spores.
Anthrax poses little risk to the average person. Veterinarians, ranchers and hunters who work, live and recreate in areas of the state where anthrax is known to occur should be aware of the disease and take precautions when finding a carcass with the classic signs of anthrax. Normal day-to-day activities pose little threat of acquiring infection.
In Texas, the anthrax triangle is an area created by connecting Uvalde, Ozona and Eagle Pass. Encompassing parts of Crockett, Edwards, Kinney, Maverick, Sutton, Uvalde and Val Verde counties, this is where most positive cases originate.
Hensley: The bacteria produce two toxins that attack various organ systems resulting in fever, depression and organ system failure. In highly susceptible animals such as cattle, sheep, deer and other herbivores, death may occur suddenly, so no signs of illness are noticed beforehand. Horses may exhibit signs of subcutaneous edema and a more protracted course of disease than cattle. Animals that die from the disease will often have bloody discharge from the orifices, absence of rigor mortis and lack blood clotting. These can all be signs of an anthrax-related death, but are not absolute without lab confirmation.
Treatment success is unlikely in animals that are severely ill when discovered. If illness is detected in the febrile stage but before other clinical signs, treatment with appropriate antibiotics may be successful.
There is an anthrax vaccine available for use in livestock species. However, the vaccine is not approved for use in dogs.
Paul: We see three to four positive cases per year. However, during 2019, Texas A&M Veterinary Medical Diagnostic Laboratory confirmed 23 positive cases in several species including cattle, white-tailed deer, goats, horses and exotic antelope.

Paul: If you see the sudden death of an animal with leakage of uncoagulated blood from natural openings, contact your local veterinarian, the Texas Animal Health Commission or Texas A&M Veterinary Medical Diagnostic Laboratory.
Hensley: People should not open a carcass suspected of anthrax. If you must handle the carcass, wear disposable gloves, a mask, long pants and a long sleeve shirt or coveralls. Launder your clothes in hot water. In anthrax endemic areas, do not pick up bones or antlers since you have no way of knowing whether the animal died from the disease or not. The spores can remain in the environment for decades.
Paul: The preferred specimen is blood collected from a superficial vein, such as the jugular. The sample should be submitted in a sterile red top or purple top anticoagulant blood tube. Swabs of bloody fluid oozing from body orifices may also be submitted in a sterile red top tube or commercial transport medium.
Although not recommended, if the carcass has been opened, the spleen, lung and liver may be submitted for bacterial culture. Ears should not be submitted for anthrax culture tests, as they are relatively avascular and are likely to yield inaccurate results.
It is important to collect samples from animals at the point of death or freshly dead as Bacillus anthracis can die in an anaerobic carcass after a period and would yield a false negative bacterial culture.
Paul: Upon arrival of anthrax-suspect samples in the lab, they are streaked onto different bacterial culture media that contain essential growth factors or nutrients for the growth of the bacterium.
The cultured media are then incubated at 98.6 degrees in aerobic condition for 48 hours. The culture media plates are examined at 24 hours and 48 hours to see if any suspected anthrax bacteria appear in the form of ground-glass, dry colonies and non-hemolytic colonies on blood agar plates. Two confirmatory tests, bacteriophage lysis and penicillin antibiotic tests, are performed on any suspected bacteria. Anthrax bacteria are positive for bacteriophage lysis and susceptible to penicillin antibiotic.
Additional information on anthrax can be found at the Texas Department of State Health Services website. Those interested in anthrax testing should call one of Texas A&M Veterinary Medical Diagnostic Laboratory’s full-service laboratories in College Station or Canyon. For more information, visit tvmdl.tamu.edu. T C
Maggie Berger is a communications specialist for Texas A&M AgriLife.











Acactus commonly found in the state’s arid regions, Horse Crippler is also known as Devil’s Head Cactus, Devil’s-Pincushion, Chisos Hedgehog

Cactus and Manca Caballo. The dark-green native cactus grows on sandy and shallow limestone sites.
Horse Crippler:

• Has one round stem up to a foot wide and 2 inches tall.
• Has up to 17 ribs per plant, with stout, cross-ribbed spines and one long central spine per areole that is curved downward.
• Has 5 to 7 radial spines per areole encircling the main central spine.
• Produces fragrant, pink-to-salmon colored, inverted bell-shaped flowers, roughly 3 inches wide and tall.
Center• Flowers have inner petals with red streaks and feathery tips.
• Produces red, fleshy fruit from the flowers.
Commonly bad news for livestock, Horse Crippler’s strong spines can badly injure the feet of grazing animals. Older plants with extremely strong spines can even penetrate vehicle and equipment tires. The plant has been eliminated from many areas because of this hazard.
Horse Crippler is one of many Hedgehog cacti cultivated for ornamental and landscape purposes. T C
The Linz Heritage Angus program consistently and uniformly delivers high-performance cattle with the most sought-after traits that not only benefit your herd, but puts you in a unique opportunity. When you work with Linz, you get the support of an entire program - from our Blue Branch Ranch breeding operations to our Timpas Feedlot and an entire processing facility with a white tablecloth customer base. Our goal is to maximize your economic success and provide our restaurant customers with high-quality Angus beef that can be traced back to the ranch and the bull that produced it.




Whenever the label permits, cattle injections should be applied subcutaneously.
However, some are labeled for intramuscular use only, including estrous synchronization products, and should be given in the animal’s neck.
A major concern is cattle may flinch when receiving intramuscular injections, which can cause the needle to bend or break.
To help prevent cattle from moving, make sure they are properly restrained in a squeeze chute. It may also be beneficial to touch or slightly rub the back of your hand on the neck prior to an intramuscular injection, reducing the reaction when administering the shot.

CONSERVE SPENDING HEALTHY. EFFICIENT. POUNDS. EFFECTIVE, EASY BREEDING

A couple of years ago we had a wreck going and needed a solution. ENDOVAC-Beef was it! A neighbor recommended the product. I knew it didn’t cost much and I knew what I was doing wasn’t working, so when I found out it covered E. coli, Salmonella, Pasteurella, and Mannheimia, I gave it a try I vaccinated my calves and it worked! Plus, it’s just so easy on them. I give it to my calves around two months of age and again at weaning. The heifers I hold back get it again in June when they go through the chute. It’s just a good product.
second year was even better because we implemented it in everything.I vaccinated my cows in April and gave them a booster in June to ensure full protection for my fall calvers and it solved all my scour problems. For those who have spring cows, I would give them a dose in the fall and again in January, about six to seven weeks before they star t calving.
Since implementing ENDOVAC-Beef, my medical bill went down and I’m just not treating calves anymore.I haven’t had to doctor one with foot rot either I can tell you that vaccinating them is cheaper than losing them… it’s wor th it. Everything that goes through the chute; cows, calves, and bulls, gets a shot of Endovac at least twice a year now.

 - JW Henson, Hillview Farms
- JW Henson, Hillview Farms
ENDOVAC-Beef has been a Game Changer for me. I run a good sized cow-calf operation in addition to star ting cattle. 100% of my cattle get ENDOVAC -Beef. Since using ENDOVAC we don’t have to treat as many cattle for respiratory, or even other common problems like pinkeye and foot rot. I am getting my Pasteurella and the stimulant that makes the vaccine work better with ENDOVAC-Beef. If everybody knew what I knew, everyone would be using it !
Lab-grown meat, which is cultured from animal cells, is often thought to be more environmentally friendly than beef because it’s predicted to need less land, water and greenhouse gases than raising cattle.
But in a preprint, not yet peer-reviewed, researchers at the University of California, Davis have found lab-grown or cultivated meat’s environmental impact is likely to be “orders of magnitude” higher than retail beef based on current and near-term production methods.
Researchers conducted a life-cycle assessment of the energy needed and greenhouse gases emitted in all stages of production and compared that with beef.
One of the current challenges with lab-grown meat is the use of highly refined or purified growth media, the ingredients needed to help animal cells multiply. Currently, this method is similar to the biotechnology used to make pharmaceuticals.
This sets up a critical question for cultured meat production: Is it a pharmaceutical or food product?

“If companies are having to purify growth media to pharmaceutical levels, it uses more resources, which then increases global warming potential,” said lead author and doctoral graduate Derrick Risner, from the university’s department of food science and technology.
“If this product continues to be produced using the ‘pharma’ approach, it’s going to be worse for the environment and more expensive than conventional beef production.”
The scientists defined the global warming potential as the carbon dioxide equivalents emitted for each kilogram of meat produced. The study found the global warming potential of lab-based meat using these purified media is four to 25 times greater than the average for retail beef.
Eventually, those researching cultured meat production seek to create lab-grown meat using primarily food-grade ingredients or cultures without the use of expensive and energy-intensive pharmaceutical grade ingredients and processes.
Under that scenario, researchers found cultured meat is much more environmentally competitive, but with a wide range. Cultured meat’s global warming potential could be between 80% lower to 26% above that of conventional beef production, the university scientists calculated. While these results are more promising, the leap from pharma to food still represents a significant technical challenge for system scale-up.
“Our findings suggest that cultured meat is not inherently better for the environment than conventional beef. It’s not a panacea,” said corresponding author Edward Spang, an associate professor in the department of food science and technology. “It’s possible we could reduce its environmental impact in the future, but it will require significant technical advancement to simultaneously increase the performance and decrease the cost of the cell culture media.”
The most efficient beef production systems reviewed in the study outperformed cultured meat across all scenarios, both food and pharma, suggesting investments to advance more climate-friendly beef production may yield greater reductions in emissions more quickly than investments in cultured meat.
The research was funded by the university’s Innovation Institute for Food and Health and the National Science Foundation Growing Convergence Research grant. T C
Amy Quinton is a news and media relations specialist, writing about agricultural research and veterinary sciences at the University of California, Davis.



There is no debate when Lorenzo Lasater says cattle ranching is in his blood.
The family ranch and L Bar brand, established by his great-grandfather, dates back to the 1870s with roots in both Texas and Mexico.
Since 1892, the brand has raised various breeds of cattle, including Hereford, Shorthorn, Jersey and Brahman. In 1937, they shifted the sole focus on developing Beefmaster genetics.
Today, Lasater serves as president of Isa Beefmasters and oversees all aspects of the operation, which is based out of San Angelo and spans eight Texas counties.
Lasater carries on the family tradition with the help of his sister, Isabel, as vice president. The siblings focus on the genetics of their herd and promoting the brand worldwide.

The importance of volunteer leadership is not lost on Lasater, whose great-grandfather was Texas & Southwestern Cattle Raisers Association’s ninth president.
“I’m a fourth-generation member and a fourthgeneration director,” Lasater says. “I went to my first TSCRA meeting as baby. It’s kind of a lifelong thing.”
In his 30-year stretch as an association member, Lasater acknowledges that while the membership composition has changed, the value remains the same. He considers government representation to be one of the top current benefits for his generation.
“The number of members we have is a tiny fraction of the U.S. population,” Lasater says. “TSCRA is representing you in Washington and Austin, and that by itself is worth the price of membership.”
Along with being on the board of directors, Lasater is currently on the marketing committee and is a past chair of the association’s promotion committee. He says one of his most memorable experiences was in the 2000s, brainstorming new ways to reach people and build membership numbers.
“As an association, we did some serious selfassessment and figured out some new things we needed to do,” Lasater says. “We started TSCRA Ranch Gatherings for those who didn’t want to come to a convention in Fort Worth.”
He says he has enjoyed seeing the local gatherings continue, encouraging members to build a community in their area, which is another benefit of membership. These connections can lead to leasing land, jobs, references and mentorships.
At the annual Cattle Raisers Convention & Expo, Lasater says he enjoys reconnecting with both new and old friends alike.
“There’s a wealth of knowledge here through directors and members,” Lasater says. “It’s worth the time to strike up a relationship with them at meetings. Everybody wants to see young people come on board and succeed.”
Aside from his network of fellow cattle raisers, Lasater considers his dad, who is now an honorary director of the association, to be his main mentor. The value he finds in being a member is undeniable, as it provides him with knowledge and resources to continue the family tradition of promoting the L Bar brand. T C













ARTHUR G. UHL 111 President
4040 Broadway St., Ste. 430 San Antonio, Texas 78209
John M. “Jack” Shelton III Amarillo, 1984-1986
James L. Powell San Angelo, 1988-1990
Tom Beard Alpine, 1994-1995
C. Coney Burgess Amarillo, 1997-1999
J. Mark McLaughlin San Angelo, 1999-2001
John E. Dudley Comanche, 2001-2003
Bob McCan Victoria, 2003-2005
C.R. “Dick” Sherron Beaumont, 2005-2007
Jon Means Van Horn, 2007-2009
Dave Scott Richmond, 2009-2011
Joe J. Parker Byers, 2011-2013
CARL RAY POLK JR. First Vice President P.O. Box 155108 Lufkin, Texas 75915
Pete Bonds Saginaw, 2013-2016
Richard Thorpe lll Winters, 2016-2018
Robert E. McKnight Jr. Fort Davis, 2018-2020

G. Hughes Abell Austin, 2020-2022
Jack Hunt San Juan Capistrano, California
Richard Wortham Austin
HEADQUARTERS
P.O. Box 101988 Fort Worth, Texas 76185 817-332-7064 • 800-242-7820
Jason Skaggs Executive Vice President/ Chief Executive Officer
Jaclyn Roberts Parrish Executive Director, Communications & Marketing
STEPHEN DIEBEL Second Vice President and Secretary/Treasurer 3907 Salem Rd. Victoria, Texas 77904


Emily Lochner
Executive Director, Engagement & Education
Grace Dunham
Executive Director, Events & Partnerships
Megan Wills
Executive Director, Finance & Human Resources
Michele Woodham Executive Director, Insurance Services
Scott Williamson
Executive Director, Law Enforcement, Brand & Inspection Services
Lisa Walker
Executive Director, Membership & Operations
GOVERNMENT RELATIONS
919 Congress Ave., Suite 750 Austin, Texas 78701
Melissa Hamilton Executive Director, Government Relations
When it comes to ranch record keeping , more people in more places use CattleMax than any other software program. That’s because , not only does CattleMax let you organize every bit of data you need, it lets you do so easily , whether you’re at home or in the field.

Joe M. “Jody” Bellah, Throckmorton
Blake Birdwell, Canyon
E. S. F. “Swasey” Brainard II, Pampa
J. K. “Rooter” Brite Jr., Bowie
Donnell Brown, Throckmorton
Campbell Burgess, Amarillo
Deborah Clark, Henrietta
Lynn Cowden, Skellytown
J. B. Daniel, Crowell
James Henderson, Memphis
Clayton Henry, Wichita Falls
Brooks Hodges, Guthrie
Joe Leathers, Guthrie
Frank McLelland, Tahoka
Jeff Mitchell, Amarillo
Gage Moorhouse, Benjamin
Diaz W. Murray, Wichita Falls
J. Malcolm Shelton IV, Amarillo
Dale A. Smith, Amarillo
Jim Thompson, Breckenridge
Tom Watson, Muleshoe
Wesley Welch, Lubbock
William L. “Buck” Arrington, Pampa
Van Baize, Nocona
Emry Birdwell Jr., Henrietta
Mary Lou Bradley-Henderson, Childress
R. A. “Rob” Brown Jr., Throckmorton
J. D. Cage, Muleshoe
Mike Gibson, Paducah
Ronald J. “Ron” Gill, Chico
Robert B. Mansfield, Amarillo
Tom Moorhouse, Benjamin
Boots O’Neal, Guthrie
James Palmer, Roaring Springs
Wilson Scaling, Henrietta
Chris Scharbauer, Amarillo
John Welch, Wolfforth
A. B. “Buck” Wharton III, Vernon
Tom Woodward, Decatur
Kevin Busher, Winters
Charles M. “Charley” Christensen Jr., San Angelo
C.A. “Chili” Cole IV, San Angelo
Alan F. Curry, San Angelo
James H. Dudley IV, Horseshoe Bay
Amanda Dyer, Fort Davis
Johnny Ferguson, Big Lake
D.A. “Day” Harral, Fort Stockton
Ron Helm, Van Horn
Heath Hemphill, Coleman
Shelby W. Horn, Fredericksburg
Larry R. Horwood, Sterling City
Grant Jones, Rochelle
Mark W. Jones, Brady
W. Clay Jones, Brady
Ty Keeling, Boerne
Lorenzo Lasater, San Angelo
Brian T. McLaughlin, Midland
David L. Neal, San Angelo
Gerald Nobles Jr., Brady
James Oliver, Ozona
Wade Perks, San Angelo
Jessica Tate, Marfa
James Uhl, Fort McKavett
Cody Webb, Barnhart
Ken Welch, Baird
Ray W. Willoughby III, Eldorado
C. A. “Chip” Cole III, San Angelo
William C. “Billito” Donnell Jr., Alpine
Richard Gates, Marfa
W. H. “Billy” Green III, Albany
Rafe Hargrove, Rotan
Dr. Joe Pat Hemphill, Coleman
Richard D. “Dick” Hughes, El Paso
Ken Jordan, San Saba
Don Keeling, Fredericksburg
Chris Lacy, Fort Davis
Laurence M. Lasater, San Angelo
Ben Love, Marathon
Len P. Mertz, San Angelo
Tom Perini, Buffalo Gap
Bill Phinizy, Gail
Frank Price, Sterling City
Gordon E. Sauer, Fredericksburg
Danny B. Stewart, Sterling City
Rick Tate, Marfa
Cliff Teinert, Albany
Dennis W. Webb, Barnhart
W. C. “Billy” Williams, Mertzon
Ford Drummond, Pawhuska, Oklahoma
Les Nunn, Pauls Valley, Oklahoma
Edward Bordovsky Jr., Riviera
Austin Brown III, Beeville
W. Christopher Bush, Refugio
James Clement lll, Kingsville
David S. Crow, Corpus Christi
Dustin Dean, Floresville
David DeLaney, Kingsville
Robert “Bobby” Dobson, Birmingham, Alabama
James L. “Jamie” Donnell Jr., Fowlerton
J. David Eppright, Cost
Benjamin Eshleman III, Corpus Christi
Joseph B.C. Fitzsimons, Carrizo Springs
Cody Fry, Lueders
Jim L. Gates, Pearsall
Milton S. Greeson Jr., Victoria
Bret Griffith, Del Rio
Heath Grigg, Kingsville
Marty R. Harris, Tilden
Leslie Kinsel, Cotulla
Claude Koontz, San Antonio
Steven J. Mafrige, Tilden
Beth Knolle Naiser, Sandia
Federico Nieto, Raymondville
T. Michael O’Connor, Victoria
Jason Peeler, Floresville
J.R. Ramirez, La Pryor
Gilly Riojas, Corpus Christi
M. Stuart Sasser, Corpus Christi
Lew Thompson, Pearsall
Gene S. “Primo” Walker Jr., Mirando City
C. Clark Welder, Beeville
John Zacek, Victoria
Steve G. Beever, Pearsall
Richard H. Bennett, San Antonio
Chip Briscoe, Carrizo Springs
Martin W. Clement II, Kingsville
Thurman S. Clements Jr., Victoria
Nixon Dillard, Pleasanton
Trainor Evans, Mercedes
Thomas J. “Tommy” Haegelin, Concan
Dr. Philip C. Hardee, Beatrice, Alabama
Allen C. “Dick” Jones IV, Corpus Christi
David W. Killam, Laredo
Dan W. Kinsel III, Cotulla
Steve C. Lewis, San Antonio
Jim McAdams, Seguin
James A. McAllen, Linn
Tim Pennell, Westhoff
Jim Peters, Quemado
Scott Petty Jr., San Antonio
Tom Risinger, Weslaco
Frates Seeligson Jr., San Antonio
Richard Traylor, Batesville
Roger F. Welder, Victoria
David W. Winters, Del Rio
Bill Cawley, Crockett
Wayne Cockrell, College Station
Herff Cornelius Jr., Wadsworth
Carlos Detering III, Houston
Dr. Lewis (Bud) Dinges, Richmond
Gardner H. Dudley, Houston
Jay C. Evans, Dripping Springs
Lloyd French IV, Houston
Dan Gattis, Georgetown
Kelley Sullivan Georgiades, College Station
George Harrison, Bay City
Tom J. Haynie, Navasota
Robert Hodgen, Houston
Colt Hoffman, Marlin
Clay Kenley, Crockett
Gary Price, Blooming Grove
Clive Runnells III, Austin
John Sumner Runnells III, Bay City
Tony Spears, Rosanky
John “Rocky” Sullivan, Galveston
Bill White, Stowell
Claudia Scott Wright, Richmond
Leroy Ezer, Anahuac
Frank Green, Liberty
Coleman H. Locke, Hungerford
Katharine Armstrong Love, Austin
Richard M. Lucas Jr., Houston
William “Alan” McNeill, Beaumont
Evalyn Moore, Richmond
Raymond E. Moore IV, Richmond
Rick Peebles, Baytown
Gordon Richardson, Caldwell
Charles R. “Butch” Robinson, Navasota
Nolan Ryan, Round Rock
Ed Small, Austin
Guy F. Stovall Jr., El Campo
Gerald Sullivan, Galveston
John L. Sullivan, Galveston
Robert J. Underbrink, Houston
Beau Brite White, Rosanky
Dr. M. R. “Mike” Wirtz, Brenham
April Bonds, Saginaw
Missy Bonds, Saginaw
John L. Cantrell, Cresson
Ian Chapman, Madill, Oklahoma
Hunter Crow, Dallas
James T. Dangelmayr, Muenster
Seth Denbow, Weatherford
Crawford Edwards, Fort Worth
John Greer, Henrietta
Jason Harlow, Dallas
Pete Hudgins, Sherman
Tom Johnson, Wortham
John Z. Kimberlin Jr., Dallas
Ken Leiber, Fort Worth
Stefan Marchman, Fort Worth
William H. McCall, Fort Worth
Dan Nance, Haslet
Susan Roach, Fort Worth
Stephen S. “Steve” Sikes, Fort Worth
Bragg Smith III, Dallas
Curtis Younts Jr., Belton
Bradford S. “Brad” Barnes, Fort Worth
George Beggs IV, Fort Worth
John W. Carpenter III, Dallas
Barrett D. Clark, Breckenridge
Markham B. Dossett, Waco
Bob Drake, Davis, Oklahoma
James H. “Jim” Dudley, Comanche
James E. “Jim” Link, Crowley
Jon David Mayfield, Dublin
C. H. “Terry” McCall, Comanche
Bob Moorhouse, Weatherford
Russell “Rusty” Noble, Ardmore, Oklahoma
Mary Joe Reynolds-Montgomery, Fort Worth
Tom L. Roach III, Bozeman, Montana
Stephen T. “Steve” Swenson, Dallas
Bart Wulff, Dallas































2 H Cattle
Mont Belvieu
3W Ranch
Channing
7J Lone Star Land & Cattle LLC
McGregor
AW Ranch LLC
Hempstead
Angela Alcala
Abilene
Todd Alexander
Palestine
B&R Ranch
Houston
David Baumann
Canyon
Bayer Ranch
Idabel, Oklahoma
Box W Ranch
Hamilton
Buckin A Ranch
Dallas
C & A Cattle Co.
Denver City
Canyon Investments Inc.
Colleyville
Cartwright’s JB Ranch
Frisco
Cattleman’s Creek Ranch
Wills Point
Corley Farm
Brownsboro
Courvilles
China
Creek Ranch/DBA Flores Ranch
Liberty
David Lehmberg GST Trust
San Antonio
Demarest Family Farm & Ranch
Gilmer
Double M Ranch
Dallas
Finch Ranch
Hedley
Fivo-O Ranch
San Diego
G Money Cattle Co.
Bridgeport
Gossett Ranch
Glen Rose
Grace & Wade Livestock LLC
Pearland
Gracey Ranch
Houston
Greer Ranch
Dallas
Hartzoge-Coronado Canyons Ranch
Midland
Antonio Herrejon
Corpus Christi
Hondo River
San Antonio
Stephen Hrbacek
La Grange
Huffaker Stone Cattle LLC
Tahoka
I Bar Ranch LLC
Putnam
Italy FFA Chapter
Grandview
Ivan Hills Ranch
Grapevine
Kelly Young Farm & Ranch
Plainview
Calrton Kempf
Castroville
Kirkham Ranch 3JF
Cleveland
Koch Farms
Waelder
L6 Ranch - Wendell C. Little Sr.
Kosse
Lazy F Ranch
Smiley
Liberty Creek Cattle Co.
Blossom
Callen Mcwilliams
Goliad
Mesquite Grove Ranch
Abilene
Mullins Ranch
Abilene
Philip Mundine
Kurten
Nichols Ranch
Glenpool, Oklahoma
Oakmound Ranch
Sweeny
Oklahoma Cattle Co.
Leander
OO Acres
The Colony
Ox Ranch
Uvalde
Robert Overton
Houston
P Bendele Farm LLC
San Antonio
Barbara Palmer
Sulphur Springs
Patterson Ranch
Dickinson
Peace on Earth Ranch
Corpus Christi
Pinecrest Farm & Ranch
College Station
Polyanna Ranch
Blooming Grove
Rafter B Cattle Co.
Cleburne
Ranchito Ramirez
Pearsall
Red Sand Land & Cattle LLC
Laredo
Caleb Rhone
Grapeland
River Bottom Ranch - Jeffrey Budde
Conroe
RL Ranch
Center Point
John Robinson
Smiley
Searcher 6 Ranch LLC
Lubbock
Sears Ranch
Denton
SH Cattle Co.
Leander
T-Shai Farms
Parker
Thompson Ranch
Cleveland
TM Cattle Co.
Corpus Christi
Ward Cattle Co.
Canton
Westview Ranch
Colleyville
WG Ranch LLC
Buffalo
Wilson Ranch
Three Rivers





























It’s about upholding traditions and growing our beef-loving community. While you keep moving forward, you can count on the Texas Beef Council having your back to drive demand for beef.






Efforts like the hit BBQuest video series surpassing 2.9 million views and delivering the latest beef nutrition research to 750 medical offices across Texas are just a few ways we’re working to keep beef in its strongest state.







Scan the QR code or visit TexasBeefCheckoff.com to sign up for the Cattle Talk newsletter and stay informed about all the ways your Beef Checkoff dollars are fueling beef demand.

Elkhart Horse Auction
Where: Elkhart
Phone: 903-764-1495
Sale Day: Saturday
Contact: Tiffany Patterson, 903-388-7288
Atascosa Livestock Exchange
Where: Pleasanton
Phone: 830-281-2516
Sale Day: Tuesday
Contact: Marvin Bendele, 210-213-5890
Four County Auction
Where: Industry
Phone: 979-357-2545
Sale Day: Tuesday
Contact: Lisa Sebastian, 979-270-3041
Muleshoe Livestock Auction
Where: Muleshoe
Phone: 806-272-4201
Sale Day: Friday
Contact: Leo Aviles, 956-437-3899
BEE
Beeville Livestock Comm.
Where: Beeville
Phone: 361-358-1727
Sale Day: Friday
Contact: Robert Bridge, 361-542-6693
Meridian L/S Comm. Co.
Where: Meridian
Phone: 254-435-2988
Sale Day: Monday
Contact: Larry Brown, 254-265-1920
Clifton Livestock Comm. Co.
Where: Clifton
Phone: 254-675-7717
Sale Day: Wednesday
Contact: Larry Brown, 254-265-1920
J & J Livestock Auction
Where: Texarkana
Phone: 903-832-3576
Sale Day: Saturday
Contact: Cheri Beal, 903-280-4554
BRAZOS
Brazos Valley Livestock Comm.
Where: Bryan
Phone: 979-778-0904
Sale Day: Tuesday
Contact: Nina Nygard, 512-281-6753
Caldwell Livestock Comm.
Where: Caldwell
Phone: 979-567-4119
Sale Day: Wednesday
Contact: Mark Nygard, 512-281-6330
Lockhart Auction
Where: Lockhart
Phone: 512-398-3476
Sale Day: Thursday
Contact: Nina Nygard, 512-281-6753
Bruce Overstreet Livestock
Where: Pittsburg
Phone: 903-856-3440
Sale Day: Monday
Contact: Michelle Willeford, 903-767-0670
Tri County Livestock Market
Where: New Summerfield
Phone: 903-726-3291
Sale Day: Saturday
Contact: Brad Dominy, 903-394-4046
Coleman Livestock Auction
Where: Coleman
Phone: 325-625-4191
Sale Day: Wednesday
Contact: Dave Williams, 325-669-2030
Cattleman’s Columbus Livestock Auction
Where: Columbus
Phone: 979-732-2622
Sale Day: Wednesday
Contact: Lisa Sebastian, 979-270-1228
Comanche Livestock Exchange
Where: Comanche
Phone: 325-356-5231
Sale Day: Saturday
Contact: Michael Davis, 254-879-3121
The New Gainesville Livestock Auction
Where: Gainesville
Phone: 940-665-4367
Sale Day: Friday
Contact: Robin Gibbs, 903-227-0791
Coryell County Comm.
Where: Gatesville
Phone: 254-865-9121
Sale Day: Saturday
Contact: Ray Davis, 254-718-5512
Cattleman’s Livestock Comm.
Where: Dalhart
Phone: 806-249-5505
Sale Day: Thursday
Contact: Clifton Miller, 806-570-7439
DEAF SMITH
Hereford Livestock Auction
Where: Hereford
Phone: 806-240-3082
Sale Day: Tuesday
Contact: Joe Bob Via, 806-452-9280
DEWITT
Cuero Livestock Comm.
Where: Cuero
Phone: 361-275-2329
Sale Day: Friday
Contact: Kaylee Malatek, 979-942-0323
EASTLAND
Texas Cattle Exchange
Where: Eastland
Phone: 254-629-2288
Sale Day: Tuesday
Contact: Ronnie Ober, 817-371-7071
ERATH
Dublin Livestock Auction
Where: Dublin
Phone: 254-445-1734
Sale Day: Friday
Contact: Ronnie Ober, 817-371-7071
Erath County Dairy Sale
Where: Dublin
Phone: 254-968-7253
Sale Day: Friday
Contact: Bob McBryde, 940-859-6217
Stephenville Cattle Co.
Where: Stephenville
Phone: 254-968-4844
Sale Day: Wednesday
Contact: Bob McBryde, 940-859-6217
FAYETTE
Flatonia Livestock Comm.
Where: Flatonia
Phone: 361-865-3538
Sale Day: Monday
Contact: Danielle Robbins, 512-944-0383
Schulenburg Livestock Auction
Where: Schulenburg
Phone: 979-743-6566
Sale Day: Saturday
Contact: Vance Weltner, 210-473-9099
Floydada Livestock Sales
Where: Floydada
Phone: 806-983-2153
Sale Day: Wednesday
Contact: JE Stone, 806-777-4396
Pearsall Livestock Auction
Where: Pearsall
Phone: 830-334-3653
Sale Day: Wednesday
Contact: Clarence Stevens, 210-415-0441
Gillespie Livestock Co.
Where: Fredericksburg
Phone: 830-997-4394
Sale Day: Wednesday
Contact: Jeff Burkes, 575-602-2280
Gonzales Livestock Market
Where: Gonzales
Phone: 830-672-2845
Sale Day: Saturday
Contact: Derek Bettis, 979-743-9699
Nixon Livestock Comm.
Where: Nixon
Phone: 830-582-1561
Sale Day: Monday
Contact: Cade Burks, 830-391-4501
Longview Livestock
Where: Longview
Phone: 903-235-6385
Sale Day: Thursday
Contact: Paul Pruitt, 903-725-6200
Mid-Tex Livestock Auction
Where: Anderson
Phone: 936-825-3970
Sale Day: Thursday
Contact: Danielle Robbins, 512-944-0383
Navasota Livestock Auction
Where: Navasota
Phone: 936-825-6545
Sale Day: Saturday
Contact: Rick Faught, 936-442-1039
Seguin Cattle Co.
Where: Seguin
Phone: 830-379-9955
Sale Day: Wednesday
Contact: Cade Burks, 830-391-4501
Hamilton Livestock Comm.
Where: Hamilton
Phone: 254-386-3185
Sale Day: Tuesday
Contact: Bob McBryde, 940-859-6217
Gore Family Auction Center
Where: Silsbee
Phone: 409-782-0612
Sale Day: Saturday
Contact: Christy McCoy, 409-782-0612
Athens Comm. Co.
Where: Athens
Phone: 903-675-3333
Sale Day: Friday
Contact: Brandy Baughman, 903-440-4382
Edinburg Livestock Auction
Where: Edinburg
Phone: 956-383-5671
Sale Day: Saturday
Contact: Coney Alvarez Jr., 956-437-3899
HILL
Hubbard Livestock Market
Where: Hubbard
Phone: 254-576-2584
Sale Day: Monday
Contact: Bob McBryde, 940-859-6217
Sulphur Springs Livestock Comm.
Where: Sulphur Springs
Phone: 903-885-2455
Sale Day: Monday
Contact: Paul Pruitt, 903-725-6200
HOUSTON
East Texas Livestock Auction
Where: Crockett
Phone: 936-544-2246
Sale Day: Tuesday
Contact: Cheyenne London, 936-222-3689
Big Spring Livestock Auction
Where: Big Spring
Phone: 432-267-5881
Sale Day: Wednesday
Contact: Bruce Brandenberger, 254-977-5763
JACKSON
Edna Livestock Auction
Where: Edna
Phone: 361-782-7666
Sale Day: Monday
Contact: Galynn Mazoch, 979-578-1823
Kirbyville Auction Barn
Where: Kirbyville
Phone: 409-423-2612
Sale Day: Saturday
Contact: Casey Jones, 409-423-0685
JIM WELLS
Gulf Coast Livestock Market
Where: Alice
Phone: 361-664-4395
Sale Day: Tuesday
Contact: Ramiro Garcia, 361-460-0008
JOHNSON
Johnson County Cattle Auction
Where: Cleburne
Phone: 817-556-9090
Sale Day: Saturday
Contact: Lee Snyder, 254-707-1682
KARNES
Karnes City Auction
Where: Karnes City
Phone: 830-780-3382
Sale Day: Saturday
Contact: Landyn Maguglin, 361-492-9484
Karnes County Livestock Exchange
Where: Kenedy
Phone: 830-583-2574
Sale Day: Thursday
Contact: Kaylee Malatek, 979-942-0323
LAMAR
Cattlemen’s Livestock Comm.
Where: Paris
Phone: 903-784-2238
Sale Day: Saturday
Contact: Robin Gibbs, 903-227-0791
Paris Livestock Auction
Where: Paris
Phone: 903-739-2575
Sale Day: Wednesday
Contact: Robin Gibbs, 903-227-0791
LAMPASAS
Lampasas Cattle Auction
Where: Lampasas
Phone: 512-556-3611
Sale Day: Wednesday
Contact: Ray Davis, 254-718-5512
LAVACA
Hallettsville Livestock Comm.
Where: Hallettsville
Phone: 361-798-4336
Sale Day: Tuesday
Contact: Kaylee Malatek, 979-942-0323
LEE
Giddings Livestock Comm.
Where: Giddings
Phone: 979-542-2274
Sale Day: Monday
Contact: Nina Nygard, 512-281-6753
Lexington Livestock Comm.
Where: Lexington
Phone: 979-773-2922
Sale Day: Saturday
Contact: Nina Nygard, 512-281-6753
LEON
Buffalo Livestock Comm.
Where: Buffalo
Phone: 903-322-4940
Sale Day: Saturday
Contact: Tyler Rader, 713-907-2725
LIBERTY
Raywood Livestock Market
Where: Raywood
Phone: 936-587-4941
Sale Day: Monday
Contact: Harvey Williamson, 963-334-5325
LIMESTONE
Groesbeck Auction & Livestock
Where: Groesbeck
Phone: 254-729-3277
Sale Day: Thursday
Contact: Tyler Rader, 713-907-2725
LIVE OAK
Live Oak Livestock Auction
Where: Three Rivers
Phone: 361-786-2553
Sale Day: Monday
Contact: Marvin Bendele, 210-213-5890
MASON
Jordan Cattle Auction
Where: Mason
Phone: 325-347-6361
Sale Day: Monday
Contact: Warren Ottmers, 830-669-2262
MCLENNAN
Waco Stockyards
Where: Waco
Phone: 254-753-3191
Sale Day: Tuesday
Contact: Larry Brown, 254-265-1920
West Auction
Where: West
Phone: 254-826-3725
Sale Day: Thursday
Contact: Ray Davis, 254-718-5512
Union Comm.
Where: Hondo
Phone: 830-741-8061,
Sale Day: Monday
Contact: Clarence Stevens, 210-415-0441
MILAM
Milam County Livestock Auction
Where: Cameron
Phone: 254-697-6697
Sale Day: Friday
Contact: Rick Faught, 936-442-1039
Nacogdoches Livestock Exchange
Where: Nacogdoches
Phone: 936-564-8661
Sale Day: Thursday
Contact: Michael Witcher, 936-556-0992
NAVARRO
Corsicana Livestock Market
Where: Corsicana
Phone: 903-872-1631
Sale Day: Tuesday
Contact: Tyler Rader, 713-907-2725
PANOLA
Panola Livestock
Where: Carthage
Phone: 903-693-6361
Sale Day: Tuesday
Contact: Lori Blankenship, 936-234-3441
POLK
Livingston Livestock Exchange
Where: Livingston
Phone: 936-327-4917
Sale Day: Saturday
Contact: Harvey Williamson, 963-334-5325
Lonestar Stockyards
Where: Amarillo Phone: 806-677-0777
Sale Day: Tuesday
Contact: Michael Vessels, 806-517-3188
RAINS
Emory Livestock Auction
Where: Emory
Phone: 903-473-2512
Sale Days: Tuesday & Saturday
Contact: Brandy Baughman, 903-440-4382
Calvert Livestock Co.
Where: Calvert
Phone: 979-364-2829
Sale Day: Friday
Contact: Ray Davis, 254-718-5512
RUSK
Hunt Livestock Exchange
Where: Henderson
Phone: 903-657-2690
Sale Day: Monday
Contact: Samuel Steadman, 318-617-1141
SAN SABA
Jordan Cattle Auction
Where: San Saba
Phone: 325-372-5159
Sale Day: Thursday
Contact: David Munden, 325-456-7253
SHELBY
Center Auction Co.
Where: Center
Phone: 936-598-4395
Sale Day: Wednesday
Contact: Michael Witcher, 936-556-0992
STARR
Triple G Livestock Auction LLC
Where: Rio Grande City
Phone: 956-437-1988
Sale Day: Friday
Contact: Coney Alvarez Jr., 956-437-3899
SWISHER
Tulia Livestock Auction
Where: Tulia
Phone: 806-995-4184
Sale Day: Thursday
Contact: Michael Vessels, 806-517-3188
TAYLOR
Abilene Auction
Where: Abilene
Phone: 325-673-7865
Sale Day: Tuesday
Contact: Dave Williams, 325-669-2030
TITUS
Stone Livestock Comm.
Where: Mt. Pleasant
Phone: 903-575-9099
Sale Day: Tuesday
Contact: Paul Pruitt, 903-725-6200
TOM GREEN
Producers Livestock Auction
Where: San Angelo
Phone: 325-653-3371
Sale Day: Thursday
Contact: Bruce Halfmann, 325-315-5972
UVALDE
Southwest Livestock Exchange
Where: Uvalde
Phone: 830-278-5621
Sale Day: Thursday
Contact: Clarence Stevens, 210-415-0441
Mort Livestock Exchange
Where: Canton
Phone: 903-287-6386

Sale Day: Special Sales Only
Contact: Paul Pruitt, 903-725-6200

WASHINGTON
Brenham Livestock Auction
Where: Brenham
Phone: 979-836-3621
Sale Day: Friday
Contact: Lisa Sebastian, 979-270-3041
WHARTON
El Campo Livestock Co.
Where: El Campo
Phone: 979-543-2703
Sale Day: Tuesday
Contact: Galynn Mazoch, 979-578-1823
Wharton Livestock Auction

Wichita Livestock Sales
Where: Wichita Falls
Phone: 940-541-2222
Sale Day: Wednesday
Contact: R.C. Langford, 832-330-7279
WILBARGER
Vernon Livestock Market LLC
Where: Vernon
Phone: 940-552-6000
Sale Day: Tuesday
Contact: Hannah Ford, 903-706-8262
WISE
Decatur Livestock Market
Where: Decatur
Phone: 940-627-5599
Sale Day: Monday
Contact: Rebecca Benson, 940-389-6382
WOOD
Winnsboro Livestock Auction
YOUNG
Graham Livestock Comm. LLC
Where: Graham
Phone: 940-549-0078

Sale Day: Monday
Contact: Kyla Rater, 940-284-9968

DAYS ARE OVER.
At 701x, we have developed a cattle management solution specially designed for ranchers who are looking for more efficient ways to manage their records and track their cattle. Save yourself time and stress by using the Autonomous Rancher® App. Use your device in the pen or pasture to quickly enter birth dates, weights, dam/sire data, as well as other fields that are important to you.


Upgrade your herd management by pairing the app with our smart ear tags, xTpro™ and xTlite™. Start tracking the activity and location of your animals no matter where you are, even offline, at the touch of your fingertips.


214.537.1285 gary@gkbcattle.com
Robert
Hogue M.D. • Judy Hogue

6 Spring Hollow, Brownwood, Texas 76801 Ranch: 10108 CR 237 • Phone: 325-643-2225 Cell: 325-647-9168

Since
Bill
Registered Black Herefords bacicafarms.com
Mike & Carla Bacica 11707 FM 2868 Flint, TX 75762

Mike: 903-520-0390
mbpga@aol.com

Carla: 903-530-8551 wtnca@aol.com
Detering Red Brahmans

Beef Oriented Red Brahmans for the pasture and the show ring Liendo Plantation, 38653 Wyatt Chapel Rd. Hempstead, TX 77445 Will Detering, owner 281.989.8965

Web site: deteringredbrahmans.com
PARTIN & PARTIN HEART BAR RANCH

Janet, Steve and Carlton Partin 3159 FM 837 • Montalba, Texas 75853 903-549-3000 • Fax: 903-549-3005


Quality Brahman Ca le Since 1936

Janet Partin: 903-922-3689 Carlton Partin: 407-709-0297 www.heartbarranch.com email: partin.partin@aol.com

5th Generation
Visitors are always Welcome
Sartwelle Brahman Ranch Ltd P O Box 27, Campbellton, Texas USA 78008
Sensibly Bred and Raised Brahman Cattle 979-877-4239
Sugie Sartwelle J. D. Sartwelle III 361-500-5792



• isabeefmasters.com


Performance Beefmasters from the Founding Family 62nd Bull Sale: October 7, 2023 Private Treaty Females Semen & Embryos BEEFMASTERS Cullin Smith (409)779-9872
www.thicketycreekfarm.com

Email: sartwellej@gmail.com
SATTERFIELD RANCH at LOST PRAIRIE LAKE • Palestine, Texas

SRegistered Gray Brahmans Dr. Scott & Nancy Satterfield 410 ACR 376 • Palestine, TX 75801 830-613-1492 www.satterfieldranch.com

ROLLING O FARMS
QUALITY CHAROLAIS BULLS & HEIFERS REGISTERED + GENTLE









D.P. OWEN + GROESBECK, TEXAS 254-729-8644







CHAROLAIS BULLS
One or a truckload - Give us a call SW&S Cattle Company
Don and Kathy Schill 903-388-1342 • Donie, Texas

T HOMAS CHAR O LAIS, INC . P.O. Box 595 • Raymondville, Texas 78580 Mitch Thomas: 956-535-0936

Tonnyre Thomas Joe: 956-535-0942 thomasra@gte.net www.thomascharolais.com

320 ac. -/+ State Lease), well watered w/three wells, two sets of steel pens. Well located just off of the Clayton/Springer hwy. on Barney Road.










PRICE RDUCED! CEDARVALE, NM – 7,113-acre ranch (5,152 ac. +/- Deeded – 1,961 ac. +/- State Lease) well fenced & watered w/good pens, new barn.






KB RANCH - Kenney Co., TX – KB Ranch is a low fenced 802 +/- acre property that is surrounded by large ranches. The ranch has abundant whitetail and is also populated with turkey, dove, quail, hogs and varmint species. Axis are in the area and have been occasionally seen. The ranch lies approximately 9 miles south of Bracketville on TX 131 and is accessed by all weather Standart Road.


RANCHES
P.O. Box 1417 Victoria, Texas 77902 361/573-7141

Traylor Division San Roque DivisionSan Carlos Division Bloomington, TX Catarina, TXRio Grande City, TX
Joe Jones-Manager • 361/897-1337
Black or Red Simbrah • SimAngus HT • SimAngus
ZC ATTLE C OMPAN Y
Joe & Beth Mercer 327 CR 459, Lott, TX 76656 • H/O/Fax: 254-984-2225 bethmercer1974@gmail.com • www.filegoniacattle.com
Foster Bros. Farms Lockney, Texas

Office:(806) 652-3351 / Fax:(806) 652-3738 David & DarLee Foster (806) 652-3824 (806) 983-7221 mbl.
fosterbros@att.net / www.fosterbrosfarms.com
Jody & Shawnda Foster (806) 652-2383 (806) 983-7225 mbl.


SIMMENTALS
Simmental & SimAngus BULL SALE
20th Annual Bull Sale
March 7, 2024
March 8, 2012
San Saba, Texas
Private Treaty Sales
Mike Mallett 10602 North Hwy. 281 • Lampasas, TX 76550
Our cattle are perfomance tested.
Mike and Connie Mallett • 512-556-1021 Lampasas, Texas • mmcmallett@outlook.com
Home: 512-556-8548 • Cell: 512-556-1021 www.mallettsimmentals.com
Registerd Texas Longhorn bulls, cows, heifers, roping steers, trophy steers, semen, mounts skulls for sale. Overnight accommodations available on the ranch.


www.stonewallvalleyranch.com
512-970-4676 (HORN) or 512-751-2386 (BEVO)
100 % Wagyu B ull s + Beef for S ale
The Ultimate in ... Calving Ease, Price Premium, and Carcass Quality


Kevin & Jessica Moore 2929 Oak Hill Rd., Alvarado, TX 76009
Kevin: 817-822-7109 • Jessica: 817-822-7402 Kevin@m6ranch.com • www.m6ranch.com

Grade Prime © Every Time!
614-778-2422 ǘN NuWAGYU.COM
Krum, Texas
Wagyu Cattle
- Seed Stock & Bulls - Semen
- Pregnancies - Embryos
Profitable • LBW • Docile • Delicious
THURSDAY, AUG. 3
Special Stocker & Feeder Sale
Where: Jordan Cattle Auction, San Saba
When: 10 a.m.
TSCRA Ranch Gathering
Where: Crockett Civic Center, Crockett
When: 5:30 p.m.
MONDAY, AUG. 7
Special Stocker & Feeder Sale
Where: Jordan Cattle Auction, Mason
When: 10 a.m.
MON., AUG. 7 - WED. AUG. 9
Texas A&M Beef Cattle Short Course
Where: College Station
TUESDAY, AUG. 15
Ranching 101: How to Calculate Cow Cost
Where: Online
When: 1 p.m.
FRI., AUG. 18 - SAT., AUG. 19
Express Ranches Annual Big Event Angus Sale
Where: Yukon, Oklahoma
SUNDAY, AUG. 20
Linz Heritage Angus: 7th Annual Female Sale
Where: Blue Branch Ranch, Byars, Oklahoma When: 5:30 p.m.
MONDAY, AUG. 21
TSCRA Ranch Gathering
Where: Courville’s, Beaumont
When: 5:30 p.m.
SATURDAY, AUG. 26
Replacement Female Sale
Where: Jordan Cattle Auction, San Saba
When: 10 a.m.
TUESDAY, AUG. 29
TSCRA Ranch Gathering
Where: NRS, Decatur When: 5:30 p.m.
SATURDAY, SEPT. 2
South Texas Cattle Marketing: “Cattleman’s Opportunity” Replacement Female Sale
Where: Nixon Livestock Comm., Nixon
When: 12 p.m.
TUESDAY, SEPT. 5
Gardiner Angus Ranch:
19th Annual Fall Production Sale
Where: Ashland, Kansas
WEDNESDAY, SEPT. 6
TSCRA Ranch Gathering
Where: 1907 Grill, Stephenville
When: 5:30 p.m.
SATURDAY, SEPT. 9
TSCRA Football Tailgate
Where: Texas Tech University, Lubbock When: 3 p.m.
SAT., SEPT. 9 - SUN., SEPT. 10
The Dale Lasater Ranch: Annual Bull Sale
Where: Matheson, Colorado
WEDNESDAY, SEPT. 13
TSCRA Ranch Gathering
Where: Jackson Family Brangus, Waco
When: 5:30 p.m.
THURSDAY, SEPT. 14
Wichita Falls Luncheon
Where: McBride’s Steakhouse, Wichita Falls
When: 11:30 a.m.
TUESDAY, SEPT. 19
Ranching 101: Bull Buyers Guide
Where: Online
When: 1 p.m.
SATURDAY, SEPT. 23
Replacement Female Sale
Where: Jordan Cattle Auction, San Saba When: 10 a.m.
MON., SEPT. 25 -WED., SEPT. 27
TSCRA Policy Conference
Where: College Station
THURSDAY, SEPT. 28
TSCRA Ranch Gathering
Where: West Texas A&M University, Canyon
When: 5:30 p.m.
FRIDAY, SEPT. 29
Jorgensen Land & Cattle: Pasture-Ready SmartBull Sale
Where: Ideal, South Dakota
When: 5:30 p.m.
SATURDAY, SEPT. 30
TSCRA Football Tailgate
Where: West Texas A&M University, Canyon
TSCRA Football Tailgate
Where: Texas Christian University, Fort Worth
TUESDAY, OCT. 3
TSCRA Ranch Gathering
Where: The Rustic, Houston When: 5:30 p.m.
WEDNESDAY, OCT. 4
2023 Halfmann-Beckton Red Angus Sale
Where: Halfmann Land & Livestock, Miles When: 1 p.m.
THURSDAY, OCT. 5
Dudley Bros.: 62nd Annual Bull Sale
Where: Comanche
THUR., OCT. 5 -FRI., OCT. 6
King Ranch Institute: 20th Annual Excellence in Ranch Management Symposium
Where: Kingsville & Online
SATURDAY, OCT. 7
Isa Beefmasters: 62nd Bull Sale
Where: San Angelo
TUESDAY, OCT. 10
Powell Herefords: 26th Annual Production Sale
Where: Fort McKavett
When: 12:30 p.m.
TSCRA Ranch Gathering
Where: R.A. Brown Ranch, Throckmorton
When: 5:30 p.m.
TUE., OCT. 10 -WED., OCT. 11
R.A. Brown Ranch: 49th Annual October Sale
Where: Throckmorton
THURSDAY, OCT. 12
Special Bull Sale
Where: Jordan Cattle Auction, San Saba When: 10 a.m.
MONDAY, OCT. 16
TSCRA Ranch Gathering
Where: First Financial Pavilion, San Angelo When: 5:30 p.m.
TUESDAY, OCT. 17
Ranching 101: Predator Control
Where: Online When: 1 p.m.
WEDNESDAY, OCT. 18
10th Annual Hill County Youth Heifer Sale
Where: Jordan Cattle Auction, San Saba When: 11 a.m.
SATURDAY, OCT. 21
TSCRA Football Tailgate
Where: Tarleton, Stephenville
WEDNESDAY, OCT. 25
TSCRA Ranch Gathering
Where: Priefert, Mt. Pleasant When: 5:30 p.m.
FRIDAY, OCT. 27
TSCRA Ranch Gathering
Where: Briggs Ranch, Victoria When: 5:30 p.m.
SATURDAY, OCT. 28
Fall “Best of the Best” Replacement Female Sale
Where: Jordan Cattle Auction, San Saba
When: 10 a.m.
44 Farms: Fall Bull Sale
Where: Cameron When: 10:30 a.m.
South Texas Hereford Association: Fall Sale, featuring Case Ranch
Where: Beeville Livestock Comm., Beeville
TSCRA Football Tailgate
Where: Texas A&M University, College Station

We didn’t just design the 6M Tractors with you in mind. We designed them with you by our side.

Before we even hit the drawing board, we talked with farmers, fleet owners and more to learn what they need in a mid-size utility tractor. Visit JohnDeere.com/6M or JohnDeere.ca/6M or contact your John Deere dealer to discover the tractor you designed—with more visibility, better maneuverability and more options to fit your needs.
The 6M. Reimagined by you. For you.
Cattlemen of the day were likely happy to hear that livestock commission rates at four major markets were reduced to the tune of about $750,000. Producers and shippers patronizing markets in Chicago, Omaha, Kansas City and St. Paul, would gain back that large sum in annual commissions. How the industry arrived at this result through USDA’s Packers and Stockyards Administration was a pioneer one, the article read.
“…it was the first time that livestock commission rates had been determined in this manner. The arbitrators held hearings at the four markets and the new rates were arrived at without the embarrassment that usually attach to formal proceedings.” T C

“ WAX Genuine Marshall ryegrass is my choice of ryegrass…been planting ryegrass for more than 20 years for grazing and hay. Majority of the time I have used WAX Marshall, but also try some of the new ryegrasses to see how they compare to my standard… WAX Marshall… I am still a WAX Marshall ryegrass man!

This past year, I tried the “Generic Marshall” from my local co-op. In short, it did not come close to production or have the carrying capacity like WAX Marshall… it looked more like Gulf… it did not have the vigor and fast recovery like WAX Marshall.
Every year is different and full of unexpected surprises, but from all my years with WAX Marshall, I feel confident in the outcome. The “Generic” just did not produce. Planting 700 acres of ryegrass, I do not need any surprises for myself or my cattle.
There has only been one consistent ryegrass for me for over 20 years… WAX Marshall ryegrass.

If you want real Marshall ryegrass, make sure you ask for WAX Genuine Marshall… I do! ”


